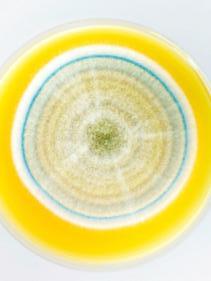

![]()





















































Sechs Suppenklassiker für kalte Tage → Seite 36
Notvorrat: Das sollten wir zu Hause haben
→ Seite 18 Halloween: So gruselt es ohne Aufwand
→ Seite 60

Gesundheit: Diese Checks braucht es
→ Seite 27
Pilze: Lösen sie all unsere Probleme?
→ Seite 52
Die ganze Welt von Cumulus finden Sie unter cumulus.migros.ch
Bei Fragen kontaktieren Sie bitte die Cumulus-Infoline: 0848 85 0848









Buchen Sie bei Interhome ein Ferienhaus oder eine Ferienwohnung in den Waadtländer Alpen und freuen Sie sich auf Winterferien mit viel Platz und privater Atmosphäre.
Aktionsdauer: für Neubuchungen vom 14.10. bis 3.11.2024 mit Reisedatum zwischen dem 30.11.2024 und dem 28.02.2025.
exlibris.ch/cumulus-angebot 10x 5x 30%


interhome.ch/cumulus
Das Lernspiel wurde in Zusammenarbeit mit Pädagogen nach dem bekannten Buch «Das Farbenmonster» von Anna Llenas entwickelt. Nutzen Sie den Code «EMOTIONEN24», um von 30% Rabatt zu profitieren.
Aktionsdauer: 14.10. bis 27.10.24
Hinweis: Das Angebot ist in allen Ex Libris-Filialen und auf exlibris.ch gültig. Der Code ist pro Cumulus-Nummer nur einmal einlösbar. Nicht kumulierbar.
Profitieren Sie von 10-fach Cumulus-Punkten auf alle Bepanthen Produkte. Sie finden uns in ausgewählten Migros-Supermärkten.
Aktionsdauer: 14.10. bis 28.10.2024
Hinweis: Die Aktion ist nicht gültig auf zurrose-shop.ch und gilt nicht für Rezepteinlösungen. Nicht mit anderen Cumulus-Aktionen kumulierbar. Nur solange Vorrat.
zurrose.ch/filialen

auf die gesamte Trevolution Bekleidung*













*Angebot gültig vom 15.10. bis 25.11.2024, inklusive Outdoorbekleidung für Kinder und Erwachsene, solange Vorrat.











20x CUMULUS
Neu
3.20

Bei diesem Angebot sind bereits reduzierte Artikel ausgenommen. Angebot gilt vom 15.10. bis 28.10.2024, solange Vorrat.

Créa d'Or Herzli
100 g
9 Editorial
Aktuell
Kurz und gut
10 News mit Würze in Kürze
Sie sind einfach Kult
14 Warum Handy, Blévita und Frey aus unseren
Haushalten nicht mehr wegzudenken sind

Kluger Rat – Notvorrat
18 Bundesrat Guy Parmelin zur neuen Kampagne des Bundes
Ratgeber
50 Stutz vörig?
23 Wie du auch kleine Beträge sinnvoll anlegst Stimmts eigentlich, dass
25 Eier mit der Spitze nach unten gelagert werden müssen?
Auf den Puls gefühlt
27 Die wichtigsten Gesundheitschecks im Überblick
Genuss
Wir bitten zu Tisch mit
30 Topmodel Manuela Frey
Feine Proteine
32 Unsere besten Ideen für Tofu, Lachs und Co.

Für den Ernstfall gerüstet
Bundesrat Guy Parmelin über mögliche Gefahrenszenarien für die Schweiz –und wieso ein Notvorrat auch in heutigen Zeiten noch angebracht ist.
S. 18
Super Suppen
36 Klassiker neu aufgelegt –und erst noch fix gemacht Wer hats erfunden?
41 Alles über Guetzli Roh oder gekocht
42 Sauerkraut schmeckt einfach immer – vor allem mit diesen Rezepten
Meine Region
45 Aktionen, Storys, News
Leben
Retten sie dereinst die Welt?
52 Pilze könnten im Kampf gegen den Klimawandel eine wichtige Rolle spielen

Oder jede Woche via Whatsapp aufs Handy:


Migros Woche Profitierenund geniessen Aktionen in der Heftmitte





Das Ohr tanzt mit
57 Eine neue Konzertreihe des Kulturprozents sprengt Klassik-Fesseln Süsses oder Saures!
60 Wie du dein kleines Monster fit für Halloween machst
Von Bachen und Keilern
62 Spannendes und Lustiges zu Wildschweinen
67 Rätsel
71 Schlussgang

Da Emilio Suppen
Zucca & Salvia, Funghi al Tartufo und Pomodoro & Basilico, z.B. Zucca & Salvia, 570 g, 6.50, (100 g = 1.14)
ab 2 Stück –.30 günstiger
Alle M-Classic Teigwaren
z.B. Fideli, 500 g, 1.80 statt 2.10, (100 g = 0.36)
2.60 Anna's Best Suppengemüse
250 g, (100 g = 1.04)
Bei allen Angeboten sind M-Budget und bereits reduzierte Artikel ausgenommen. Angebote gelten vom 15.10. bis 21.10.2024, solange Vorrat.
MIGROS-MAGAZIN
vormals Wir Brückenbauer, Wochenblatt des sozialen Kapitals, Organ des MigrosGenossenschafts-Bundes (MGB)
ONLINE: migros.ch/magazin
ADRESSE: Limmatstrasse 152, Postfach 1766, 8031 Zürich
TELEFON: 0800 840 848
KONTAKT: www.migmag.ch/leser
HERAUSGEBER: MGB
CHEFREDAKTORIN: Sabine Eva Wittwer
AUFLAGE: 1 477 714 Ex. (Wemf, Auflagenbulletin 2023)
LESERSCHAFT: 2 235 000 (Wemf, MACH Basic 2024-1)
ABONNEMENTE: www.migmag.ch/abo
TELEFON: 058 577 13 00*
Ausführliches Impressum auf www.migmag.ch/impressum
M-INFOLINE:
TELEFON: 0800 840 848
CUMULUS-INFOLINE:
TELEFON: 0848 850 848*
* 8 Rp./Min. aus dem Schweizer Festnetz
Was wurde der damalige Armeechef André Blattmann ausgelacht!
Vor zehn Jahren erwähnte er in einem Interview beiläufig, er habe etwa 300 Liter Mineralwasser als Notvorrat zu Hause. Seine Aussagen sorgten international für belustigte bis hämische Kommentare. Das deutsche Magazin «Der Spiegel» höhnte: «Schweizer Armeechef hortet Notvorräte und rät der Bevölkerung, ihm nachzueifern.»
Seither gab es: eine Pandemie, einen Kriegsausbruch in Europa, unterbrochene Lieferketten, Strom und Gasknappheit, Naturkatastrophen. Heute lacht niemand mehr über Notvorräte.
Wir haben erlebt, dass auch das Undenkbare Realität werden kann. Deshalb rufen Bund und Detailhandel in einer neuen Kampagne dazu auf, eine kleine Notreserve zu halten. Bundesrat Guy Parmelin sagt im Interview mit dem MigrosMagazin: «Es kann immer etwas Unvorhergesehenes passieren. Deshalb sollten alle einige Tage autonom leben können.»
Denn wer zuletzt lacht, lacht am besten.

Christian Dorer Leiter Direktion Kommunikation Migros-Gruppe
Seit wann gibt es den Notvorrat?
Vor dem Zweiten Weltkrieg wurde die Bevölkerung angehalten, Notreserven anzulegen. Eine Reaktion auf Hamsterkäufe im Ersten Weltkrieg. Im Kalten Krieg wurde der Notvorrat Standard.
Wie etabliert ist er heute?
Gemäss einer Studie von 2021 haben nur 32 % der Befragten regelmässig genügend Lebensmittel sowie Getränke vorrätig. Bei 48 % liegen die Vorräte meist unter den Empfehlungen.
Und während der Pandemie?
Im ersten Lockdown legte gut die Hälfte der Bevölkerung mehr Notvorräte an als üblich. Bei Männern war das Bedürfnis, einen Notvorrat anzulegen, rund 17 % geringer als bei Frauen.

1
Vorsicht beim Essen: abends Süsses, Koffein, Alkohol und Rohkost möglichst meiden.
Ein Drittel der Schweizer Bevölkerung leidet an Schlafstörungen. Gehörst du dazu? Drei Tipps, wie es besser gehen könnte. Gericht
Damen Pyjama reine Biobaumwolle, GOTS-zertifiziert Fr. 39.95
Smartphone weglegen: Das blaue Licht des Displays hemmt die Produktion von Melatonin, das den Schlaf-WachRhythmus steuert.

Schlafzimmerklima: Optimal sind 16 bis 18 Grad und eine Luftfeuchtigkeit von 40 bis 60 Prozent. Unter der Decke sollte es möglichst konstant rund 30 Grad warm sein.

Herren Pyjama reine Biobaumwolle, GOTS-zertifiziert Fr. 26.95 statt 44.95

Hier gehts zum Migusto-Rezept:

Ab Donnerstag, 17. Oktober, könnt ihr euch für einen der 18 Migros Ski Days anmelden. Beim Schneesporttag für die ganze Familie sind inbegriffen: Plauschrennen, Tageskarten, Mittagessen, Medaille, Last-Minute-Check für Ski und Snowboards, Familiengeschenk und euer persönliches Rennvideo. Alles zum unschlagbaren Preis von 120 Franken (für Mitglieder von Famigros oder Swiss-Ski 95 Franken).
Alle Infos und Anmeldung: migros-ski-day.ch
20 ×

V-Love Wings
195 g Fr. 5.50

V-Love Pops

160 g Fr. 4.95 V-Love Sweet Potato Puffs
190 g Fr. 4.50
Drei neue V-Love-Stars
Die Migros hat alles, was du für deine pflanzenbasierte Ernährung brauchst. V-Love-Produkte wie die neuen Wings, Pops und Puffs bieten viel Abwechslung und vor allem Genuss. Hinzu kommt, dass ihre Herstellung weniger Land und Wasser verbraucht als herkömmliche tierische Produkte.
Aktion: 20-fach Cumulus-Punkte vom 15. bis 28. 10.





LEISTUNGEN - ALLES SCHON DABEI!



✓ Fahrt im komfortablen Extrabus ✓ 3 Übernachtungen im Mittelklassehotel im Puster-/Eisacktal ✓ 3 x Frühstück im Hotel ✓ 2 x Nachtessen im Hotel ✓ 1 x Südtiroler SpezialitätenNachtessen ✓ Besuch der Weihnachtsmärkte von Brixen, Meran & Bozen ✓ Eintritt & reservierte Plätze für das Adventskonzert der Kastelruther Spatzen am 13.12.2024 (Kat. B) ✓ Eigene Schweizer Reiseleitung während der ganzen Reise
Ihr tolles Reiseprogramm:
1. Tag - Fahrt im komfortablen Extrabus ins schöne Südtirol. Nachtessen im Hotel.
2. Tag - Brixen, die älteste Stadt Tirols empfängt uns mit dem bekannten Dom, traditionsreichen Lauben und einem schönen Adventsmarkt. Am Nachmittag fahren wir nach Kastelruth, schlendern über den kleinen Adventsmarkt und erleben dann das stimmungsvolle Adventskonzert mit den legendären Kastelruther Spatzen. Nachtessen im Hotel.
3. Tag - Heute entdecken wir mit Meran und Bozen die zwei schönsten Weihnachtsmärkte des Südtirols. Geniessen Sie den herrlichen Geruch von süssen Leckereien und würzigem Glühwein. Am Abend erwartet uns im Hotel zum Abschied einen feinen Südtiroler Spezialitäten-Abend.
4. Tag - Nach dem Frühstück treten wir die Heimreise an.


Ihr Reisedatum: 12. - 15. Dezember 2024
Preis pro Person im Doppelzimmer im guten Mittelklassehotel Fr. 639.-
Nicht inbegriffen/zusätzlich wählbar: Einzelzimmerzuschlag: Fr. 90.Buchungsgebühr: Fr. 24.- pro Person (Entfällt bei Online-Buchung)
Sie wählen Ihren Bus-Einsteigeort: Aarau, Basel, Bern, Luzern, Pfäffikon SZ, Thun, St. Gallen, Sargans, Winterthur, Zürich





Tiroler Adventszauber & unvergessliche Privatkonzerte
LEISTUNGEN - ALLES SCHON DABEI!
4 Reisetage inkl. Halbpension, ab nur
✓ Fahrt im komfortablen Extrabus ✓ 3 Übernachtungen in der gewählten Hotelkategorie ✓ 3 x Frühstück im Hotel ✓ 3 x Nachtessen im Hotel ✓ Besuch der Weihnachtsmärkte in Innsbruck, Pertisau,Rattenberg & Kitzbühel ✓ Romantische Adventsschifffahrt auf dem Achensee ✓ Herrliche Winter-Dampfzugfahrt mit der Zillertalbahn
REISEHIT 25 im Doppelzimmer
✓ Eintritt & reservierte Plätze für die Adventsgala in Kirchberg mit Francine Jordi & Oesch’s die Dritten (Kat 2) ✓ Eigene Schweizer Reiseleitung während der ganzen Reise
Ihr tolles Reiseprogramm:
1. Tag - Fahrt im komfortablen Extrabus nach Innsbruck, wo uns der stimmungsvolle Weihnachtsmarkt erwartet. Weiterfahrt in unser charmantes Tiroler Hotel, herzlicher Empfang mit Begrüssungsgetränk und Nachtessen.
2. Tag - Besuch der zauberhaften Kleinstadt Rattenberg mit stimmungsvollem Adventszauber. Anschliessend romantische Adventsschifffahrt auf dem Achensee. Nach dem Nachtessen im Hotel erwartet uns in Kirchberg unsere festliche Adventsgala mit Privatkonzerten von Francine Jordi & Oesch’s die Dritten.
3. Tag - Nostalgische Bahnfahrt mit der Zillertalbahn durch die herrliche Winterlandschaft, danach können Sie die weihnachtliche Atmosphäre in Kitzbühel geniessen. Der Tag endet mit einem gemütlichen Nachtessen im Hotel.
4. Tag - Nach dem Frühstück geht es mit zauberhaften Erinnerungen zurück nach Hause.

Ihr Reisedatum:
5. - 8. Dezember 2024
Preis pro Person im Doppelzimmer Im 3-Sterne Hotel: Fr. 799.Im 4-Sterne Hotel: Fr. 859.-
Nicht inbegriffen/zusätzlich wählbar: Einzelzimmerzuschlag: Fr. 99.Buchungsgebühr: Fr. 24.- pro Person (Entfällt bei Online-Buchung)
Sie wählen Ihren Bus-Einsteigeort: Aarau, Basel, Bern, Luzern, Pfäffikon SZ, Sargans, St. Gallen, Thun, Winterthur, Zürich

Weihnachtsmarkt in Innsbruck
Mit gezielten Übungen kann Face Yoga zu Entspannung und einem frischeren Erscheinungsbild beitragen. Für straffere Wangen zum Beispiel: Forme deine Zeigefinger zu einem C und lege sie neben deine Nasenflügel. Massiere die Haut sanft nach aussen in Richtung der Ohren. Wiederhole die Übung einige Male.
Jetzt anmelden für den Onlinekurs «Face Yoga» der Klubschule Migros:

Weitere Rabatte bei Ex Libris: Noch bis Ende Oktober zahlen Kunden und Kundinnen 10 Prozent weniger für Sachbücher und Ratgeber sowie Bücher auf Französisch. Zudem gibt es 20 Prozent Rabatt auf ausgewählte E-Books und alle E-Reader-Modelle.
10–20 %
Rabatt

«Ich denk, ich denk zu viel» Nina Kunz, Kein + Aber, 192 Seiten, kartonierter Einband Fr. 13.30 statt 14.80, E-Book Fr. 9.50 statt 11.90 Erhältlich bei exlibris.ch
Eine Orange mit Nelken gegen Käsegeruch oder Backpulver gegen hartnäckige Verkrustungen im Pfännchen: Weitere nützliche Tipps gibts auf Migusto – und in der Migros speziell für die Raclette-Saison diese Beilagen:

Condy Cornichons Weissweinessig
125 g Fr. 2.20

Condy Silberzwiebeln Balsamico
125 g Fr. 1.80

Condy Champignons Kräuteressig
130 g Fr. 2.95

Kultprodukte
Handy-Spülmittel von 1958 bis heute: ganz links die erste Flaschenform, ganz rechts die von 1961. Die Flasche mit den Punkten kam 1976, ganz vorn steht die aktuelle.
Sie haben in der Schweiz Kultstatus: Wie viele Blévita-Cracker jährlich gegessen werden, wann die Frey-Schoggi ins Flugzeug kam und wie das Handy-Spülmittel zum Aprilscherz wurde.

Text: Barbara Scherer
Kultprodukte
Ein Spülmittel mit Kultstatus: In welchem Land gibts das schon? Bei uns, und zwar seit 1958.
Die Marke Handy führte die Migros 1958 ein. Der Name kommt vom englischen Wort handy und bedeutet so viel wie handlich, praktisch oder griffbereit.
Während der vergangenen zwölf Monate wurden schweizweit rund 3,9 Millionen Produkte der Marke Handy gekauft; auch HandyProdukte wie Nachfüllbeutel und Sondereditionen wie «Fresh Ocean» oder das pinke Handy.
erlaubte sich die Migros in Huttwil BE einen Aprilscherz. Am 31. März wurde in einem Inserat im Lokalblatt angepriesen, dass es am kommenden Tag «Handy für nur einen Franken» geben werde. Damals war das sogenannte Natel C beliebt. Schon früh standen also am Morgen des 1. April Kunden vor der Migros, um dann festzustellen, dass mit «Handy» kein Natel, sondern das Spülmittel gemeint war.

2023
kam das blaue Handy «Fresh Ocean» in die Migros. Die Verpackung besteht aus upcyceltem Plastikabfall, der an Küsten und Stränden gesammelt wird. Damit leistet jede einzelne Flasche einen Beitrag zum Schutz der Ozeane.

Die Schokoladenmarke der Migros hat ein Einhorn im Logo. Warum eigentlich? Hier erfährst dus.
Seit 1887 gibt es die Chocolat Frey, und sie ist damit eine der ältesten Schokoladen der Schweiz. Seit 1950 gehört die Schokoladenmarke der Migros.
Die Gebrüder Max und Robert Frey haben die Firma Chocolat Frey gegründet. Sie haben der Schokolade nicht nur ihren Familiennamen gegeben, sondern auch das Wappentier der Familie Frey: das Einhorn. Es ist bis heute fester Bestandteil des Frey-Logos.

1937
kostete eine FreyTafelschokolade 40 Rappen. Die Preise haben sich –wie alle Preise – im Lauf der Zeit verändert: Heute kostet eine Tafel FreyMilchschokolade etwa Fr. 1.95.




Bei allen Angeboten sind bereits reduzierte Artikel ausgenommen.
Angebote gelten vom 15.10. bis 21.10.2024, solange Vorrat.















12 Stunden Wärme für den Rücken.
Nach Aktivierung der Wärmezellen entfaltet sich eine intensive und langanhaltende Wärme. Das patentierte Butterfly Design ermöglicht dabei eine optimale Wärmeverteilung. Insbesondere am Rücken führt eine Wärmebehandlung zu Entspannung und Wohlbefinden.
selbstwärmend einfache Handhabung bequem und diskret
Fortsetzung von Seite 15
Seit 2015 arbeiten
Chocolat Frey und die Fluggesellschaft Swiss zusammen. Fluggäste erhalten bei jedem Flug ein Schöggeli der Marke Frey. Im März 2024 wurde bekannt, dass die Fluggesellschaft die Zusammenarbeit für weitere drei Jahre verlängert.
Chocolat Frey ist seit 2013 von der «Rainforest Alliance» zertifiziert. Das bedeutet, dass die Schokolade unter ökologisch, sozial und wirtschaftlich nachhaltigen Bedingungen produziert wird.


Kultprodukte

Blévita ist ein Gebäck mit Suchtpotenzial. Zum Glück gibt es inzwischen 50 verschiedene Sorten.

1969
hat die Migros den Getreidecracker Blévita erfunden.
Der Name Blévita setzt sich aus «le blé» (Korn) und «vita» (Lebenskraft) zusammen. Der Name heisst also so viel wie: «Das Korn, das Leben schafft».
78 %
der Schweizerinnen und Schweizer kennen die Marke Blévita, wie eine Studie des Marktforschungsinstituts GfK aus dem Jahr 2023 zeigt.
Knusprig, praktisch, reisetauglich: Es soll Auswanderer geben, die mit Blévita-Vorräten um den halben Globus reisen.
500 000 000
Pro Jahr werden in der Schweiz mehr als 500 Millionen Blévita Cracker gegessen.



50 Es gibt mehr als 50 verschiedene Blévita Sorten. Zu den ersten gehörten «Original», «Classic» und «Sesam». Noch heute haben alle CrackerSorten gemeinsam, dass sie viele Ballaststoffe und weniger als 2 Gramm Salz pro 100 Gramm enthalten.
«Alle sollten einige Tage autonom leben können»

Bundesrat Guy Parmelin erklärt, wie sich die Schweiz gegen verschiedene Gefahrenszenarien rüstet – und wieso ein Notvorrat auch in heutigen Zeiten noch angebracht ist.
Herr Bundesrat, wie sieht
Ihr persönlicher Notvorrat aus?
Sie denken bestimmt an meinen Weinvorrat (lacht). Spass beiseite: Meine Frau und ich haben immer genug Wasser im Haus sowie Reis und Kartoffeln für etwa eine Woche. Dazu auch etwas Bargeld.
Weshalb braucht es das?
Es kann immer etwas Unvorhergesehenes passieren. Deshalb sollten alle einige Tage autonom leben können. Man sollte auch an Medikamente denken oder an Futter für die Haustiere. Eine Taschenlampe ist ebenfalls nützlich.
Wieso startet die Notvorrat-Kampagne gerade jetzt?
Während der Coronapandemie und der Energiekrise waren die Menschen sensibilisiert. Jetzt herrscht wieder eine gewisse Nonchalance. Mein Eindruck ist: Gerade junge Leute und Städter meinen, sie könnten in jedem Fall sofort und überall etwas zu essen kaufen. Dem ist leider nicht immer so. Als Einstiegshilfe gibt es neu einen Notvorratsrechner. Damit können alle leicht herausfinden, was sie im Haushalt vorrätig haben sollten.
Reden wir über die einzelnen Bedrohungen: Wie wahrscheinlich ist ein militärischer Konflikt?
Die Welt hat diverse Brandherde mit offenem Ausgang. Die Lage ist sehr ernst. Alle Länder wollen ihre Armeen aufrüsten, auch die Schweiz muss das zwingend tun. Die Kampfjets F-35 und das Patriot-Luftabwehrsystem sind ein Anfang.
Wie schlimm wäre ein grossflächiger Stromausfall?
Gravierend! Alles hängt am Strom. Besonders bei einem länger andauernden und grossflächigen Blackout ist ein Notvorrat wichtig.
Müssen wir uns an häufige Naturkatastrophen gewöhnen?
Wir müssen versuchen, mögliche Schäden zu minimieren – und das braucht Investitionen. Ich besuchte Luzern während des Hochwassers von 2021. Wären zuvor nicht
«Es herrscht wieder eine gewisse Nonchalance.
Gerade junge Leute und Städter meinen, sie könnten sofort immer und überall etwas zu essen kaufen.»
Bundesrat Guy Parmelin
mehrere Millionen Franken investiert worden, wären die Auswirkungen noch schlimmer gewesen.
Dauert es wieder 100 Jahre bis zur nächsten Pandemie?
Wir wissen nicht, wann die nächste Pandemie kommt. Wir wissen nur, dass sie kommen wird. Leider werden uns die Lehren vom letzten Mal nur bedingt helfen, weil jede Pandemie anders ist. Sollten zum Beispiel junge statt alte Menschen besonders gefährdet sein, bräuchte es andere Massnahmen.
Wie bedrohlich sind Cyberattacken?
Viele kleinere Unternehmen unterschätzen diese Gefahr stark. Jedes kann Opfer werden. Ich war froh zu sehen, dass Schweizer Informatiker in Lyon Weltmeister in Cybersecurity geworden sind.
Welche Rolle in der Landesversorgung haben Detailhändler wie die Migros?
Eine sehr wichtige! In der Pandemie haben sie grosse Flexibilität gezeigt. Die Menschen wussten: Wenn ich in den Laden gehe, finde ich alles. Deshalb kam es nur am Anfang zu Hamsterkäufen, als diese Gewissheit noch nicht vorhanden war.
Die Schweiz hat einen Selbstversorgungsgrad von 49 Prozent. Das heisst, nur knapp die Hälfte der Lebensmittel wird im Inland produziert. Reicht das? Wenn es weniger würde, wäre das gerade für eine nächste Krise gefährlich. Dazu habe ich eine Anekdote: Der indische Handelsminister sagte mir einst, die Schweiz solle aufhören, landwirtschaftliche Produkte herzustellen – Indien könne alles viel günstiger liefern. Einige Jahre später stoppte Indien den Export wegen Dürre. Das zeigt: Die Lage kann sich schnell ändern. In der Krise hat man keine Freunde mehr. Dann schaut jedes Land für sich.
Eben. Was macht unser Land in der Krise, wo es die Hälfte der Lebensmittel importiert?
Die Schweiz hat Pflichtlager an Reis, Öl, Saatgut, Benzin und Weiterem mehr. In einer
Notvorrat
Bundesrat Guy Parmelin empfiehlt, einen Notvorrat anzulegen, um Hamsterkäufe zu vermeiden.

ernsthaften Krise müssten wir aber auch beim Konsum ansetzen und zum Beispiel unsere Gewohnheiten etwas in Richtung pflanzlicher Ernährung ändern.
Die Bauern sind enorm wichtig für die Landesversorgung. Im Frühling gab es vereinzelt Protestaktionen. Was tun Sie, damit die Situation nicht eskaliert wie in unseren Nachbarländern?
Die Bauern haben zwei Anliegen: Sie wollen höhere Preise für ihre Produkte und weniger administrative Belastung im Alltag. Wir haben Schritte in diese Richtung eingeleitet. Ein Beispiel: Neben staatlichen Kontrollen gibt es auch Kontrollen für private Labels wie IP-Suisse oder Bio. Hier könnte eine bessere Koordination den administrativen Aufwand reduzieren.
Und die Preise?
Druck kommt von beiden Seiten: Die Bauern möchten möglichst hohe Preise und die Konsumentinnen möglichst wenig bezahlen. Dazwischen befinden sich die Verarbeiter und der Handel. In dieser Kette braucht es nicht volle, aber doch etwas mehr Transparenz bei der Preisbildung. Das sollte wenn möglich freiwillig geschehen. Denn es besteht ein grosser Druck aus dem Parlament für neue gesetzliche Vorgaben.















Trinken ist wichtiger als Essen. Und Kerzen, Energiequellen sowie Medikamente gehören auch in den Notvorrat.
Text: Nina Huber
Der Bund empfiehlt, einen Notvorrat zu pflegen. Dazu lanciert er einen Onlinerechner, der den Bedarf für den eigenen Haushalt auflistet (siehe Box). Es geht darum, dass jede Person die ersten Tage einer Versorgungslücke, zum Beispiel bei einem Stromunterbruch oder bei Hochwasser, überbrücken kann.
Das gehört in den Notvorrat Es gilt die Faustregel: Jede Person in einem Haushalt sollte Trinkwasser für drei Tage auf Reserve haben, also 9 Liter Wasser pro Person. Weiter Lebensmittel für eine Woche, eine Taschenlampe, Kerzen, Batterien oder andere Energiequellen sowie die wichtigsten Medikamente. Mit Vorteil enthält der Notvorrat auch Esswaren, die nicht zubereitet werden müssen, wie Zwieback, Apfelmus und Trockenfrüchte. Eine kleine Menge an Bargeld gehört ebenfalls in den Notvorrat sowie WC-Papier, Hygienemasken, Seife und Desinfektionsmittel.
Den Vorrat laufend verbrauchen und ersetzen Auch wenn sich der Notvorrat sinnvollerweise aus Lebensmitteln zusammensetzt, die lange haltbar sind, sollte er regelmässig verbraucht und frisch ersetzt werden. Darum ist es wichtig, dass die Esswaren den persönlichen Gewohnheiten und Bedürfnissen entsprechen. Idealerweise sorgt der Vorrat mit Klassikern wie Reis und Teigwaren nicht nur für eine Zufuhr an Kohlenhydraten, sondern deckt mit Hülsenfrüchten, Konserven, Trockenwurst und Öl auch den Bedarf an Proteinen, Vitaminen und Fetten.
Lagern mit System Grundsätzlich sind trockene, kühle und dunkle Orte am besten geeignet, um Lebensmittel zu lagern. Optimalerweise die Packungen nach Mindesthaltbarkeit sortieren: Was weniger lang hält, darf in der Reihe weiter vorn stehen.





Anzeige




Notvorrat






Eine beispielhafte Auswahl an Dingen, die für einen Notvorrat wichtig und geeignet sind: Neben Wasser und haltbaren Lebensmitteln gehören auch Medikamente, Körperpflegeprodukte, Batterien, Kerzen, Streichhölzer und Bargeld dazu.

Klug vorsorgen
Neu kannst du online auf der Website des Bundesamts für wirtschaftliche Landesversorgung einfach die Anzahl Personen mit dem jeweiligen Alter eingeben, die in deinem Haushalt leben, und schon stellt der Rechner dir eine Liste aus mit den individuellen Angaben für dich und deine Familie. Hier kannst du es ausrechnen lassen:
CHF 15.– Gutschein für Ihr CEWE FOTOBUCH* mit dem Code 2856 migros.ch/photo

Ihre schönsten Reiseerinnerungen im CEWE FOTOBUCH.


Portofreie Lieferung in Ihre Filiale
Cumulus Punkte sammeln
Bequeme Heimlieferung
*Aktion gültig bis 03.11.2024 für alle CEWE FOTOBUCH Varianten, ab einem Mindestwarenwert von CHF 50.–. Nur einmal pro E-Mail-Adresse einlösbar. Nicht kumulierbar.
Jetzt scannen und direkt loslegen:


Erhältlich in grösseren Migros-Filialen.
Bei diesem Angebot sind bereits reduzierte Artikel ausgenommen. Angebot gilt vom 15.10. bis 21.10.2024, solange Vorrat.

IBAN CH68 0900 0000 8000 8955 1 Winterhilfe Schweiz Clausiusstrasse 45, 8006 Zürich






Bei allen Angeboten sind bereits reduzierte Artikel ausgenommen.
Angebote gelten vom 15.10. bis 28.10.2024, solange Vorrat.
Spenden an die Winterhilfe Schweiz werden in der ganzen Schweiz eingesetzt.
QR-Code für online-Banking und Twint
























Geldanlagen

Frage
Ich habe monatlich 50 Franken zum Anlegen übrig. Wie gehe ich am besten vor?

Angélique
Schweizer
Kundenberaterin
Migros Bank, Expertin für Anlagethemen
Antwort
Bei kleineren Beträgen legst du dein Geld am besten in einem Sparplan bei einer Bank an. Der Plan ermöglicht dir, regelmässig Geld beiseitezulegen. Du wählst einen festen Betrag, der monatlich oder vierteljährlich von deinem Konto abgebucht wird. Dies hilft dir, eine Sparroutine zu etablieren und deine finanziellen Ziele zu erreichen.
Das Geld, das du mithilfe eines Sparplans ansparst, kannst du zum Beispiel in einen Fonds anlegen. Darin sind Aktien mehrerer Unternehmen sowie Obligationen oder weitere Anlagen enthalten. Die Dividenden und Zinserträge, die du auf dein angelegtes Geld erhältst, werden laufend investiert. So erzielst du eine Rendite auf deine Rendite
(Zinseszinseffekt), dein Vermögen kann langfristig exponentiell anwachsen.
Weil du regelmässig investierst, kommt es nicht darauf an, genau den richtigen Zeitpunkt zu erwischen. Zudem fallen Kursschwankungen bei einem langen Anlagehorizont weniger ins Gewicht. Je länger der Horizont, desto niedriger ist das Risiko negativer Renditen. In den vergangenen 100 Jahren gab es nur drei Jahre, in denen die ZehnJahresRendite negativ ausfiel.
Die meisten Sparpläne sind flexibel. Das heisst, du kannst die Höhe deiner Beiträge ändern oder den Sparplan jederzeit stoppen, wenn sich deine finanzielle Situation ändert und du Geld aus dem Fonds benötigst.
Willst du einen Fondssparplan einrichten, kannst du dich entweder für einen börsengehandelten Indexfonds oder für einen aktiv gemanagten Fonds entscheiden: Ein börsengehandelter Indexfonds (ETF) bildet einen bestimmten Aktienindex ab, zum Beispiel den MSCI World. Das heisst, der Fonds entwickelt sich identisch wie dieser Index.
Bei einem aktiv gemanagten Fonds kümmern sich dagegen Fondsmanager um dein Vermögen. Sie streben eine bessere Wertentwicklung als der Gesamtmarkt an. Bei der Migros Bank kannst du schon ab 50 Franken pro Monat in einen breit investierten Fonds der Migros Bank investieren.
Ob aktiv oder passiv gemanagt: In einem Fonds wird dein Geld immer auf eine Vielzahl von Anlagen verteilt. Damit lässt sich das Risiko von Verlusten besser abfedern, als wenn du dein Geld in eine Einzelanlage investierst. Zudem musst du nicht alle Anlagen einzeln auswählen und überwachen, was Zeit und Fachwissen erfordert.
Tipp: Achte bei der Wahl eines Anlageprodukts auch auf anfallende Gebühren, etwa für das Depot und die Käufe von Wertschriften. Bei einem Fondssparplan der Migros Bank sind die Depotgebühren um die Hälfte reduziert und Käufe und Verkäufe kostenlos.
In einen Fondssparplan investieren
Weitere Informationen zum Fondssparplan der Migros Bank sowie einen Prognoserechner findest du hier:
Werbung für eine Finanzdienstleistung gemäss FIDLEG
Publireportage
Wir sind hier, damit es Dir leichter fällt, gut zu leben. Wir nehmen das Beste aus Obst und Gemüse und machen daraus Smoothies und Säfte. Die schmecken gut und tun gut. Und wusstest Du, dass Du mit Säften und Smoothies von innocent nicht nur Dir selbst etwas Gutes tust? Wir spenden jedes Jahr zehn Prozent unseres Gewinns für gute Zwecke.

im Kühlregal
Mit extra Vitaminen
















…
dass Eier mit der Spitze nach unten gelagert werden müssen?
Geht es um die Frage nach der richtigen Lagerung von Eiern, müssen wir keinen Eiertanz aufführen. Im Grunde ist es einfach: Eier fühlen sich kopfüber am wohlsten. Die Spitze sollte also nach unten zeigen. Der Grund: Am «dicken» Ende verfügt das Ei über eine Luftkammer. Liegt diese Luftkammer unten, steigt die Luft mit der Zeit nach oben. Dadurch kann sich die Eihaut ablösen, und Keime können leichter eindringen. Also: Spitze nach unten, sodass der Eidotter auf dem Eiweiss und nicht auf der Luftkammer liegt – und das Ei bleibt länger frisch.
Kühlschrank oder nicht?
Beides geht, aber nicht zu jedem Zeitpunkt: Bis 21 Tage nach Legedatum verfügen die Eier über einen natürlichen Schutz. Während dieser Zeit würde ein Küken heranwachsen, wenn es ausgebrütet würde. Kühle Temperaturen könnten diese Schutzschicht schädigen, und Bakterien hätten ein leichtes Spiel, ins Ei zu gelangen. Deshalb findest du die Eier in der Migros auch nicht im Kühlregal, somit kannst du sie zu Hause auch bei Raum
temperatur lagern. Wichtig ist, dass sie dabei nicht direkter Sonneneinstrahlung ausgesetzt sind. Sind die drei Wochen vorbei, gehören die Eier in den Kühlschrank. Dort mögen sie allerdings nicht allzu kalte Temperaturen, deshalb ist die Kühlschranktür der beste Ort. Mit Vorteil lagerst du die Eier nicht neben stark riechenden Lebensmitteln wie Käse, denn durch die dünne Schale könnten fremde Aromen eindringen.
Sind gekochte Eier länger haltbar? Kochst du zu Hause ein Ei, solltest du es innerhalb von fünf Tagen essen. Denn im kochend heissen Wasser verliert die Schale ihre natürliche Schutzschicht. Lagere das hart gekochte Ei daher im Kühlschrank. Anders steht es um die gekochten Eier aus der Migros, dort liegt das Mindesthaltbarkeitsdatum bei 40 Tagen – und zwar, weil sie gefärbt sind. Dabei werden die Poren der Eierschalen geschlossen, wodurch keine Keime mehr eindringen können.
Text: Nina Huber
Die Migros bekämpft
Die Migros verkauft Toastbrot mitsamt Anschnitt. Oder Trockenfleisch- und Rohschinkenanschnitte zu günstigeren Preisen. Die Bemühungen, Restprodukte zu verwerten, gehen aber noch weiter. So führte die Migros dieses Jahr drei neue vegane Fleischersatzprodukte ein, die auf Basis von Biertreber bestehen. Treber sind die Rückstände der Braugerste, aus denen Malz für die Bierproduktion gewonnen wird. Gegen
Zum Beispiel mit Resteverwertung


































Entdecken Sie die Schokoladenwelt von Villar s !
Entdecken Sie die Schokoladenwelt von Villar s !

Villars gibts in Ihrer Migros






Auf den Puls gefühlt: Viele Risikofaktoren
lassen sich erst im individuellen
Gespräch mit einer Ärztin oder einem Arzt ermitteln.
Vorsorgeuntersuchungen

Ab welchem Alter solltest du deinen Darm spiegeln lassen? Oder deinen Blutdruck messen? Die wichtigsten Vorsorgeuntersuchungen im Überblick.
Text: Nina Huber
«Vorsorgeuntersuchungen sind wichtig, aber noch wichtiger sind persönliche Besprechungen mit einer Vertrauensärztin oder einem Vertrauensarzt», sagt Christian Ambrosch, Leiter Medbase Winterthur Neuwiesen. Denn viele Risikofaktoren lassen sich erst im individuellen Gespräch ermitteln. Da viele Krankheiten schleichend verlaufen, ergeben gewisse routinemässige Checks Sinn. Gemeinsam mit einer Ärztin oder einem Arzt könne man abwägen, wie gross der individuelle Nutzen oder die Risiken seien, so Ambrosch.
Fortsetzung auf Seite 29






Immunsystem

Emmi Aktifit z. B. Erdbeere, 6 x 65 ml 20%



Emmi Jogurt PUR z. B. Erdbeer, 150 g 20%




Emmi I’m your Meal z. B. Choco, 500 ml 20% Für die Extraportion Protein 20% Aktion auf alle Emmi






Bei allen Angeboten sind bereits reduzierte Artikel ausgenommen. Angebote gelten vom 15.10. bis 21.10.2024, solange Vorrat. Bester Arabica Kaffee, eisgekühlt

Alle Emmi Energy Milk High Protein z. B. Vanille, 330 ml 20%



Alle Emmi CAFÈ LATTE z. B. Macchiato, 230 ml 20%



Emmi Luzerner Rahmkäse ca. 220 g 20%

Fortsetzung von Seite 27
Vorsorgeuntersuchungen
Blutdruck
«Eine der sinnvollsten Vorsorgeuntersuchungen ist die Blutdruckmessung. Das kann man auch günstig in Apotheken machen», sagt Ambrosch. Denn ein erhöhter Blutdruck bleibt oft unerkannt, kann aber Blutgefässe schädigen und Folgeerkrankungen nach sich ziehen. Bei normalem Blutdruck (<130/85) reicht eine Messung ab 18 Jahren alle drei Jahre, ab 40 einmal jährlich. Bei erhöhtem Blutdruck empfiehlt sich eine medizinische Beratung.
Blutzucker
Ein krankhaft erhöhter Blutzuckerspiegel kann über eine Blutentnahme festgestellt werden. Da der Diabetes Typ 2, auch Altersdiabetes genannt, über einen langen Zeitraum unbemerkt verlaufen kann, wird ein generelles Screening ab 40 Jahren empfohlen. Je nach individuellem Risiko (Übergewicht, erhöhter Blutdruck, familiäre Vorbelastung) alle ein bis drei Jahre.
Blutfett
Der Anteil an Fett im Blut gibt Aufschluss über eine Fettstoffwechselstörung mit erhöhtem Risiko für Gefäss- und Herzerkrankungen. Die Messung durch Blutentnahme wird ab 40 Jahren empfohlen und dann je nach Risikoeinschätzung alle zwei bis fünf Jahre wiederholt.

Wie gesund bist du?
Der Medical Check Basic von Medbase bietet eine medizinische Standortbestimmung des persönlichen Gesundheitszustands. Die Untersuchungen und Diagnostik dauern circa zwei Stunden am Vormittag, am Nachmittag erfolgt eine Besprechung anhand der Blutanalysen und Laborwerte mit einer Ärztin und einem Präventionsberater. Du erhältst individuelle Verbesserungsvorschläge und Tipps für deine Gesundheit.
Mehr Infos zum Check:
Brustkrebs und Gebärmutterhalskrebs
Hier kommt es stark auf die Vorbelastung an. Bei bekanntem Brustkrebsgen empfiehlt sich eine Mammografie für Frauen bereits ab 30 Jahren. Bei familiärer Vorbelastung ab 40. Ohne Vorbelastung deckt die Krankenkasse zwischen 50 und 74 eine Röntgenaufnahme der Brust in Rücksprache mit einem Arzt oder einer Ärztin alle ein bis drei Jahre. Der Nutzen ist umstritten. Hinweise auf Gebärmutterhalskrebs geben veränderte Zellen. Es reicht ein Krebsabstrich bei Frauen zwischen 21 und 70 Jahren einmal alle drei Jahre.
Bei einem Prostatakrebs-Screening wird mittels Blutentnahme ein spezifisches Antigen ermittelt, das Hinweise auf mögliche Tumorzellen gibt. Der Test ist nicht zu hundert Prozent zuverlässig. Er wird empfohlen für Männer mit familiärer Vorbelastung zwischen 50 und 69 in Absprache mit der Hausärztin oder dem Urologen.
Die routinemässige Früherkennung von Darmkrebs ist eine der effektivsten Präventionsmassnahmen, empfohlen ab 50. Es gibt zwei Möglichkeiten: eine Darmspiegelung alle zehn Jahre, wobei eine Kamera eingeführt wird. Oder eine Untersuchung des Stuhls alle zwei Jahre, eine günstigere und weniger aufwendige Alternative. Enthält der Stuhl Blut, erfolgt eine Darmspiegelung.
Einen Hinweis auf Hautkrebs bilden veränderte Muttermale. Gute Selbstbeobachtung ist die halbe Miete. Bei auffälligen Hautveränderungen oder bei mehr als 50 Muttermalen sollte ab 18 Jahren eine Hautärztin oder ein Hautarzt beigezogen werden. «Die wichtigste vorbeugende Massnahme ist, direkte Sonneneinstrahlung insbesondere bei heller Haut in jungen Jahren zu verringern», sagt Christian Ambrosch.

Manuela Frey

Aufgedeckt
«Ich

nicht in einem ausgehungerten»
Manuela Frey hat die Zeiten hinter sich, in denen sie
Kalorien gezählt hat. Wieso das international gefragte Model heute lieber mehr wiegt – und was für sie unbedingt auf die Pizza gehört.
Text: Dinah Leuenberger
Manuela Frey, wie sieht ein typisches Frühstück für Sie aus?
Unter der Woche trinke ich einen Proteinshake. Am Wochenende gehe ich mit Familie oder Freunden in meine Lieblingsrestaurants – in Zürich ins «Samigo Amusement» oder in die «Milchbar». Brunch ist für mich das Highlight der Woche!
Wie essen Sie Ihr Ei am liebsten?
Als Rührei, mit viel Salz.
Essen Sie vor einem Shooting oder einem Auftritt?
Ja, aber nur etwas Leichtes, zum Beispiel Früchte mit Joghurt. Wenn ich zu viel esse, kann ich mich nicht mehr konzentrieren.
Was essen Sie danach?
Da darf es üppig sein. Nach einer Show zum Beispiel gern Pizza und Rotwein.
Als Model wird man nach seinem Äusseren beurteilt. Welchen Einfluss hat das auf Ihre Essgewohnheiten? Früher habe ich penibelst auf mein Gewicht geachtet. Das war hart. Ich wog bestimmt 15 Kilogramm weniger als heute. Ich habe meine Laufstegzeiten geliebt, aber es war auch sehr anstrengend – vor allem mental, und die Ernährung spielte dabei eine grosse Rolle. Heute fühle ich mich wohler in meiner Haut. Ich möchte in einem gesunden Körper leben, nicht in einem ausgehungerten.
Welches Vorurteil über Models in Bezug auf Essen nervt Sie?
Wenn ich in Gesellschaft esse, höre ich oft: «Wow, du isst ja! Ein Model isst!» Das mag ich nicht.
Was war Ihr Lieblingsessen als Kind? Kartoffelstock. Dazu gab es in Butter gebadete Rüebli mit einer Prise Zucker.
Und jetzt?
Ganz klar: Fondue oder Raclette. Je mehr Käse, desto besser.
Wie passen Sie auf Reisen Ihre Ernährung an verschiedene Länder und Kulturen an?
Ich liebe es, neue Dinge zu probieren. Daher fällt es mir nicht schwer, mich anzupassen. In Südostasien zum Beispiel esse ich oft am Strassenrand oder bei den herumziehenden Tuktuks. Die Gerichte werden mit frischen Zutaten direkt vor meinen Augen zubereitet. Ich liebe zum Beispiel Pad kra pao, also Reis mit Spiegelei und Gemüse.
Was bestellen Sie beim Roomservice? Entweder einen Caesar-Salat mit Pommes frites oder ein Omelett.
Was war das ungewöhnlichste Gericht, das Sie jemals auf einer Ihrer Reisen probiert haben?
Ungewöhnlich war das Injera in Äthiopien zwar nicht, aber ungewöhnlich gut! Das ist ein weiches Fladenbrot aus Sauerteig – auch die Schärfe der Beilagen mochte ich sehr. Ich habe das Gericht bereits am Flughafen probiert und konnte kaum mehr aufhören.
Welche Küche mögen Sie am liebsten? Die italienische: Pasta, Pizza und alles, was dazugehört.
Was gehört f ür Sie auf eine Pizza? Nichts. Ich mag Pizza Margherita, also nur Tomatensauce, Mozzarella und Oregano.
Aufgedeckt

Manuela Frey (28)
lebt im Kanton Aargau und gewann mit 16 den Schweizer «Elite Model Look»-Contest. Seither feiert sie internationale Erfolge als Laufsteg- und Fotomodel. Zudem hat sie TV-Formate wie «Switzerland’s next Topmodel» moderiert sowie 2023 die Talentagentur Just M&R mitgegründet.
Was mögen Sie nicht?
Fleisch. Ich habe mich dazu entschieden, vegetarisch zu leben, weil ich immer weniger Fleisch ass. Heute gibt es viele tolle Alternativen zu Fleisch.
Wie viel Platz nimmt Essen in Ihrem Leben ein?
Ich fühle mich gut, wenn ich gesund und ausgewogen esse. Und am Tisch sitzend, nicht zwischendurch im Stehen. Leider kommt das trotzdem immer wieder mal vor, wenn ich viel zu tun habe und unterwegs bin oder lange Arbeitstage habe.
Zählen Sie Kalorien?
Nein, nicht mehr. Früher tat ich es. Ich weiss zwar noch immer ungefähr, was wie viele Kalorien hat, aber ich nehme es nicht so streng. Früher habe ich von 1000 Kalorien pro Tag gelebt, heute sind es etwa 2500.
Haben Sie auch Diäten gemacht?
Natürlich, Hunderte davon. Eine Diät ist nicht unbedingt schlimm, sie kann auch ein Lifestyle sein. Wichtig ist jedoch: Man sollte auf keinen Fall hungern.
Wie oft trinken Sie Alkohol?
Gelegentlich am Wochenende, aber nie übermässig viel.
Was ist Ihr Guilty Pleasure?
Erdnussbutter. Die streiche ich auf eine Scheibe Sauerteigbrot – die perfekte Kombi!
Kochen Sie selbst? Was können Sie gut? Ja, natürlich. Bei mir kommt gesundes Essen auf den Tisch. Auch Lasagne gelingt mir gut. Für Gäste koche ich gern Veggieburger.
Wer hat Ihnen das Kochen beigebracht? Meine Mama.
Was ist Ihr liebstes Küchengerät? Meine De’Longhi-Kaffeemaschine. Ich liebe Kaffee, am liebsten als Iced Coffee und meistens mit Milch. Egal ob Kuhmilch oder Milchalternative – ich mag beides.
Was haben Sie immer im Kühlschrank? Schokolade. Die macht definitiv glücklich.
Mit wem essen Sie am liebsten?
Mit meiner Familie und meinen Freunden.
Und mit wem würden Sie gern einmal essen gehen?
Mit George Clooney habe ich bereits Kaffee getrunken und angeregte Gespräche geführt. Für einen Zmittag hat es bisher leider noch nicht gereicht.

Mit Tofu bekommt man 15 Gramm Protein pro 100 Gramm auf den Teller. Kombiniert mit Ei erhält man ein schmackhaftes Gericht. Zum Rezept «TofuNudeln mit Ei und Gurkensalat» gehts hier lang:
Proteine

Du möchtest mehr Lebensmittel mit hohem Eiweissgehalt essen? Wir zeigen dir die grössten Proteinlieferanten im Alltag – samt Rezeptvorschlägen.
Text: Claudia Schmidt

Lachs gilt mit 20 Gramm Protein pro 100 Gramm als eiweissreicher Fisch. Mit Lachs gelingen schnelle und einfache Gerichte, zum Beispiel «Lachs mit exotischem Fruchtsalat».
Mit 20 bis 26 Gramm Protein pro 100 Gramm – je nachdem, von welchem Teil des Tiers es stammt – ist Rindfleisch als Eiweisslieferant sehr beliebt. Wenn man das Fleisch mit anderen proteinhaltigen Lebensmitteln kombiniert, etwa mit Edamame, den unreif geernteten Sojabohnen, erhält man eine Mahlzeit mit gutem Proteingehalt. Rezept: «Rindfleisch mit Edamame»

Das Weizenprotein Gluten ist Hauptbestandteil von Seitan. Deshalb zeichnet er sich durch einen Proteingehalt von 22 Gramm pro 100 Gramm aus. Er enthält mehr Eiweiss als Tofu. Seitan nimmt besonders gut Marinaden und Gewürze auf und ist perfekt für Gerichte wie die «Kokossuppe mit Seitan».

Linsen punkten mit 27 Gramm Protein pro 100 Gramm. Der Proteingehalt sinkt um circa die Hälfte, wenn sie sich beim Kochen mit Wasser oder Bouillon vollsaugen.
Dennoch ein feiner und vielseitiger Proteinlieferant, etwa als «Linsen-Rosenkohl-Dal».


Nicht nur zum Apéro beliebt: Trockenfleisch enthält 38 Gramm Protein pro 100 Gramm. Auch wenn man nicht so viel davon isst, peppt es ein Gericht auf, etwa in der «Kürbisquiche mit Bündnerfleisch».

Mit 22 Gramm Protein pro 100 Gramm ist die Pouletbrust eine gute Quelle für Eiweiss. Eine Extraportion kommt hinzu, wenn man sie mit ebenfalls proteinreichem Parmesan kombiniert. «Pouletbrust mit Parmesan und Tomaten»:
Proteine für unterwegs

Bar 45 g Fr. 1.50

M-Budget Protein
& Cream Bar 45 g Fr. 1.50 M-Budget Protein








Toilettenpapier aus FSC®-zertifizierten Wäldern und kontrollierten Quellen
Verpackungen bestehen aus 50 % rezykliertem Kunststoff und sind rezyklierbar

Kimberly-Clark ist auf dem Weg, die CO2-Emissionen zu reduzieren



Verpackung aus 30 %* rezykliertem Kunststoff
100 % sicher hinunterspülbar
*in Bezug auf die Kunststofffolie
Erkundigen Sie sich in Ihrer Medbase Apotheke nach Sandoz-Generika.
www.medbase-apotheken.ch





Jetzt

Süss, sauer, salzig – diese


Diese Suppen sind von Klassikern inspiriert, können aber im Nu in etwas ganz Spezielles verwandelt werden – und das in maximal 30 Minuten Kochzeit.

Rezept
suppe mit Biberli-SpeckMöckli
Hauptgericht für 4 Personen
300 g gekochtes Sauerkraut
1 Zwiebel
50 g rote Linsen
1 EL Erdnussöl
6 dl Gemüsebouillon
150 g Frischkäse mit Kräutern Salz Pfeffer
Biberli-Speck-Möckli
2 Biberli, z. B. gefüllte à ca. 75 g
8 Tranchen Bauernspeck
1. Sauerkraut kalt abspülen und gut abtropfen lassen. Zwiebel hacken. Mit Linsen im Öl andünsten. Sauerkraut beigeben. Mit Bouillon ablöschen. Suppe 15 Minuten köcheln lassen.
Suppen


Die pürierte Randensuppe mit Joghurt, Sprossen und Randenpickles besticht nicht nur durch ihren Geschmack, sondern auch mit ihrer schönen Farbe.
2. Biberli in ca. 1,5 cm grosse quadratische Würfel schneiden. Mit je einer Specktranche umwickeln. Möckli in einer Bratpfanne rundum scharf anbraten.
3. Zum Servieren etwas Sauerkrautmischung aus der Suppe heben und beiseitestellen. Suppe mit einem Stabmixer pürieren. Frischkäse nach und nach daruntermixen. Suppe mit Salz und Pfeffer abschmecken. Mit beiseitegestellter Sauerkrautmischung anrichten. Biberli-Speck-Möckli separat dazuservieren.
Kürbissuppe mit Ras al-Hanout und Limette
Die nordafrikanische Gewürzmischung Ras al-Hanout sowie die Schale und der Saft einer Limette geben der Kürbissuppe eine orientalische Note.


Senfcremesuppe mit Bretzelcroûtons
Senf gibt der mit Lauch und Gemüsebouillon zubereiteten Cremesuppe Geschmack. Mit gerösteten Bretzelcroûtons ein Hauptgericht.
Selleriesuppe mit Kräuteröl
Vorspeise für 4 Personen
400 g Knollensellerie
200 g gebleichter Lauch
2 Schalotten
2 Knoblauchzehen
2 EL Öl
1 dl Weisswein oder Zitronensaft
1 l Gemüsebouillon
2,5 dl Sonnenblumenöl

40 g Kräuter, z. B. Schnittlauch oder glatte Petersilie
1 dl Rahm
Salz
50 g Röstzwiebeln
1. Sellerie, Lauch, Schalotten und Knoblauch klein schneiden. Gemüse im Öl andünsten. Mit Wein ablöschen. Mit Bouillon auffüllen. Suppe ca. 15 Minuten köcheln lassen, bis das Gemüse sehr weich ist.
2. Fürs Kräuteröl eine Schüssel mit Eiswasser vorbereiten. Ein Sieb mit einem Kaffeefilter oder einem Gazestück auskleiden. Kräuter grob hacken. In einen Mixer mit hoher Leistung geben. Öl auf 60–70 °C erhitzen. Zu den Kräutern giessen. Fein pürieren. Kräuteröl durch den Kaffeefilter oder die Gaze in eine Schüssel sieben. Diese ins Eiswasser stellen und das Öl auskühlen lassen. Rahm zur Suppe giessen. Suppe mit einem Stabmixer möglichst fein pürieren. Mit Salz abschmecken. Anrichten. Mit Kräuteröl und Röstzwiebeln servieren.

Hauptgericht für 4 Personen
1 Zwiebel
2 Knoblauchzehen
400 g mehligkochende Kartoffeln
3 EL Rapsöl
200 g Federkohlblätter, gerüstet gewogen 1,2 l Gemüsebouillon
Salz
Pfeffer
ca. 8 blaue Kartoffeln, z. B. St. Galler
4 EL Kürbiskerne
150 g Feta
Zwiebel und Knoblauch hacken. Mehligkochende Kartoffeln in feine Scheiben schneiden. Öl in einem hohen Topf erhitzen. Zwiebel, Knoblauch und Kartoffeln ca. 3 Minuten darin dünsten. Federkohlblätter dazugeben. Mit Bouillon ablöschen und zugedeckt 25–30 Minuten bei mittlerer Hitze köcheln lassen. Suppe pürieren. Mit Salz und Pfeffer abschmecken. Inzwischen die blauen Kartoffeln separat in Salzwasser weich kochen und in dünne Scheiben schneiden. Kürbiskerne hacken. Suppe mit Kartoffelscheiben und Kürbiskernen anrichten. Feta darüberbröseln und sofort servieren.
TIPP Suppe nach Belieben mit Olivenöl beträufeln.

Gemüsiges
Gemüse ist wohl die dankbarste Suppenzutat überhaupt: Du kannst so ziemlich alles miteinander kombinieren und somit den Kühlschrank leeren. Lampige Rüebli, welker Federkohl oder gummiger Lauch erwachen im Suppentopf zu neuem Leben. Ebenso schrumpelige Kartoffeln, Peperoni oder nicht mehr ganz frischer Blumenkohl.
Geflügeltes
Laut Grosis auf der ganzen Welt wirken Hühnersuppen kraftspendend. Wie dem auch sei, garantiert ist jedenfalls das wohlig-warme Sättigungsgefühl, das sich nach ihrem Verzehr ausbreitet. Du brauchst dafür kein ganzes Suppenhuhn zuzubereiten, auch gezupfte Pouletreste vom Vortag eignen sich gut, zum Beispiel in einer Bouillon oder in einer Nudelsuppe. Übrigens: Bratenreste vom Rind oder Schwein machen sich gut in der asiatischen Nudelsuppe.
Knuspriges
Einer sämigen Suppe tut etwas Knuspriges immer gut. Das kann zum Beispiel eine Minikäseschnitte mit altem Brot sein, selbst gemachte Croûtons aus altem Toast, die Reste in der Chips- oder Popcornpackung oder in Essig Eingelegtes wie Gurken, Zucchetti, Silberzwiebeln. Auch im Ofen gebackener Federkohl sorgt für Knuspriges.
Suppen
Im Kühlschrank liegen Lebensmittel, die ihre besten Tage hinter sich haben? Dann heisst die Devise: Suppe, Suppe und noch mal Suppe. Vor allem jetzt, da es draussen kühler wird.

Du hast ein aromatisiertes Öl geschenkt bekommen, vergisst aber ständig, es zu verwenden? Ab in die Suppe damit! Je nach Intensität mit einigen Tropfen beginnen, bei Bedarf mehr hinzugeben. Auch geriebener Parmesan oder sonstiger Käse verleiht der Suppe ein sensorisches Upgrade. Noch cremiger und ein kleines bisschen edel wird deine Restesuppe mit einem pochierten Ei.
Reste von Linsen, Pasta, Bohnen, Couscous oder Kichererbsen übrig? Oder die Dose zuhinterst im Vorratsschrank nach Jahren wiedergefunden? In Bouillon aufkochen und dann je nach Zutat klar servieren (etwa Pasta oder Couscous) oder mit dem Pürierstab sämig pürieren (Linsen, Bohnen, Kichererbsen), dabei eventuell mit Flüssigkeit auffüllen, damit die Suppe nicht zu dick wird.
Text: Dinah Leuenberger, Naomi Hirzel
Da passt jede Suppe rein


Frischhaltedose 550 ml Das Gefäss eignet sich für die Lagerung und den Transport von Suppen. Fr. 3.95

Jetzt von 20x Cumulus profitieren.

Nimm einfach Ricola Mit der Kraft von 13 Schweizer Alpenkräutern

20x
CUMULUS MULUS
Neu

6.50 Ricola Kräuterzucker 400 g (100 g = 1.63)
Bei allen Angeboten sind bereits reduzierte Artikel ausgenommen. Angebote gelten vom 15.10. bis 28.10.2024, solange Vorrat.
20x
CUMULUS MULUS


Neu
4.60 Ricola Gletscherminze 125 g (100 g = 3.68)

Guetzli

Süsses Knuspergebäck gibt es, seit der Mensch das Backen entdeckt hat. Wirklich kreativ wurden Guetzlimacher aber erst im 19. Jahrhundert.
Im Gegensatz zum übrigen deutschsprachigen Raum reden wir in der Schweiz nicht von Keks, sondern von Guetzli. Wir meinen aber natürlich dasselbe wie alle anderen: ein knuspriges, süsses Gebäck, das zu Kaffee und Tee gegessen wird, in besonders grossen Mengen während der Weihnachtszeit. Die Idee, ein kleines Gebäck zu kreieren, ist so alt wie das Backen selbst und stammt aus vielen Kulturen rund um die Welt.
Lange haltbar
Was wir heute unter Keks verstehen –eben das knusprige, süsse Gebäck –, wurde vermutlich im Mittelalter erstmals gebacken. Und zwar in Belgien und den Niederlanden. In den Niederlanden bedeutet das Wort «koekje» kleiner Kuchen, davon stammt auch die Bezeichnung Keks ab. Seeleute assen diese Kekse auf ihren langen Reisen, denn sie enthielten wenig Feuchtigkeit
Gibts in der Migros

Créa d’Or Herzli
100 g Fr. 3.20
* Aktion: 20-fach CumulusPunkte vom 15.–28. 10.
Neu!*
und waren daher lange haltbar. In grossen Mengen produziert wurden die Kekse seit der Industrialisierung im 19. Jahrhundert. Dabei spielte auch die Erfindung des noch heute bekannten Leibniz-Kekses eine zentrale Rolle. Die deutsche Firma Bahlsen erfand ihn 1891 und benannte ihn nach dem Philosophen und Mathematiker Gottfried Wilhelm Leibniz. Und zwar, weil dieser aus Hannover stammt, wie auch die Firma Bahlsen. Der Keks wurde zum Erfolg.
Ab diesem Zeitpunkt wurde die Geschichte des Guetzli vielseitig: Varianten mit Schoggi, mit Nüssen oder Spritzteig kamen auf den Markt, Guetzli mit Konfitüre, Glasur oder Dekoration. In der Migros gibt es inzwischen über 250 verschiedene Guetzli-Sorten, die allerneueste ist ein hauchdünnes Butterherzli der Marke Créa d’Or.
Text: Dinah Leuenberger
Rohes Sauerkraut
DAS IST ES
Sauerkraut ist Weisskabis, der fein gehobelt und mit Salz vermengt wurde. Er vergärt während mehrerer Wochen. Diesen Prozess nennt man Fermentation.
SO BEWAHRT MANS AUF
Durch die Fermentation wird das Gemüse lange haltbar. Das rohe Sauerkraut im Beutel aus der Migros bleibt im Kühlschrank mehrere Wochen frisch.
SO SCHMECKTS
Bei der Fermentation entwickelt das Sauerkraut seinen typisch pikant-säuerlichen Geschmack. Rohes Sauerkraut hat mehr Biss als die gekochte Variante. Wer seiner Darmflora etwas Gutes tun und die Milchsäurebakterien des rohen Sauerkrauts erhalten möchte, sollte es nicht erhitzen, sondern kalt geniessen.
DAS GIBTS DAZU
Das Kraut schmeckt in Salaten, in einem Sandwich oder zu Gschwellti und Käse. Auch die koreanische Variante Kimchi ist sehr beliebt: Die würzige, kalte Beilage serviert man in Korea zu fast allen Mahlzeiten.
Sauerkrautsalat
Einfach, schnell, gesund: Aus Sauerkraut, Granatäpfeln, Äpfeln, Joghurt und Honig lässt sich im Handumdrehen ein herrlicher Salat zaubern.
Ob roh oder gekocht ist Geschmacksache. Beide Varianten eignen sich für vielfältige Rezepte von leicht bis deftig.
Text: Angela Obrist




Weissweinsuppe mit Sauerkraut und Croûtons
Für die würzige WeissweinSauerkraut-Rahm-Suppe wird Sauerkraut mit Lauch und Kartoffeln gekocht und püriert. Gekühlt ist sie auch an heissen Tagen ein Hit.


Sauerkraut
DAS IST ES
Das fixfertige, gekochte Sauerkraut produziert man wie das rohe Sauerkraut mittels Milchsäuregärung. Anschliessend wird es aber noch pasteurisiert oder sterilisiert.
SO BEWAHRT MANS AUF
Gekochtes und pasteurisiertes Sauerkraut hält sich oft einige Jahre frisch, auch ungekühlt. Selbst gemachtes Sauerkraut im Glas ist im Kühlschrank etwa drei Monate haltbar.
SO SCHMECKTS
Gekochtes Sauerkraut hat ein milderes Aroma als die rohe Variante. In der Migros findet man es gewürzt mit Kümmel oder Wacholderbeeren. Die Spezialität Weinsauerkraut ist zudem mit Weisswein abgeschmeckt.
In der Schweiz kommt Sauerkraut traditionell zu deftigen Gerichten auf den Tisch. Bei der «Berner Platte» begleitet es Salzkartoffeln, Dörrbohnen, Speck und Rippli. Wenn man das Kraut mit Pouletfleisch und würzigem Paprika kombiniert, kann man ein ungarisches «Szegediner Gulasch» kochen. Gekochtes Sauerkraut passt auch prima in eine Suppe, auf einen Flammkuchen oder in einen Hotdog im New-York-Stil.





































































Das Leben wird immer schneller, und oft bleibt kaum Zeit für ein ausgewogenes Frühstück oder Zmittag. Wenn dann der Hunger kommt, greifen wir nicht selten zum nächsten Snack –schnell bleibt da die Qualität auf der Strecke.
Emmi I’M YOUR MEAL vereint jetzt eine Mahlzeit und erfrischenden Genuss in einem schmackhaften Drink, ganz ohne Laktose.
PASST PERFEKT ZU DEINEM LIFESTYLE
Wer viel auf Achse ist und zwischen Familie, Freunden und Job jongliert, braucht Pausen – und vor allem regelmässig wertvolle Energie.

















* pro Flasche






























Die Emmi I’M YOUR MEAL Trinkmahlzeit ist die clevere Alternative wenn’s schnell gehen muss. Mit einer Flasche geniesst du eine gehaltvolle Stärkung mit 38 g * Protein, Ballaststoffen sowie 26 Vitaminen und Mineralstoffen –genau das, was dein Körper braucht, um wieder voll durchzustarten.


















Lang sättigend





38 g* Protein 26 Vitamine & Mineralstoffe













ZWEI LIEBLINGSSORTEN –EIN GENUSS





Ob zügiges Zmorge im Bus, sättigende Mahlzeit-Alternative über Mittag oder Power-Znacht nach Feierabend – Emmi I’M YOUR MEAL ist sofort griffbereit in den zwei beliebten Sorten Choco und Vanilla, natürlich in bester Emmi Qualität. Eat smart. Drink.








Probiere jetzt





Emmi I’M YOUR MEAL und prof i tiere von CHF 3.– Cashback!





















































1 Bottle = 1 Meal

CHF 3.00
QR Code auf der Flasche scannen und Geld zurück erhalten


Auszahlung via







































































Die Kindermusikband Silberbüx nimmt gern singend ihr Publikum auf eine Reise voller Glück und Abenteuer mit. Im Theater Arlecchino zeigen sie ein unvergessliches Programm, das es nicht zu verpassen gilt.
Steffi, Maurice und Benno können Klein und Gross begeistern – mit ihren Hits und neuen Songs zaubern sie lachende Gesichter und wippende Füsse in die Konzertsäle. Sei es, gemeinsam in der Baumhütte auf ewige Freundschaft zu schwören oder den geheimnisvollen Keller im Schopf zu entdecken. Die Drei reissen einen wortwörtlich mit, durch witzige und spannende Fälle und Alltagsgeschichten.
Seit fast 15 Jahren spielen Steffi Hess, Benno Muheim und Maurice Berthele als Silberbüx auf Bühnen und entwickeln Kinderkonzerte, die im Herzen in Erinnerung bleiben. Die einzigartige Art und Weise, ihre Konzertprogramme interaktiv und inszeniert durchzuführen, hat sie zu
starken Performern gemacht, die auf eine erfolgreiche und preisgekrönte Karriere zurückschauen können. Für ihre junge Fanbase gehören Silberbüx zu den ganz Grossen der Musikszene.
Der Auftritt von Silberbüx ist der Auftakt der MigrosKinderkonzertreihe im Theater Arlecchino. Mehr Infos zu den drei weiteren Konzerten gibt es auf theaterarlecchino.ch.
* 5 × 2 Tickets für die Vorstellung am 10. November, 11 Uhr Teilnahme: E-Mail mit Betreff Silberbüx an verlosung@migrosbasel.ch
Am Räbeliechtliumzug laufen die Kinder stolz mit ihren selbst geschnitzten Liechtli durch die Dunkelheit und erhellen mit ihrem Gesang die Gassen. Wer sich vorgenommen hat, an einem der Räbeliechtliumzüge in Basel (am 13. November) oder in Liestal (am 7. November) teilzunehmen, sollte rechtzeitig mit dem Schnitzen beginnen. Der Fantasie sind dabei keine Grenzen gesetzt. Damit das Kunstwerk gelingt, bietet die Migros Basel auch in diesem Jahr wieder Räben und Bastelmaterial für 1 Franken an. Ab 15. Oktober können in folgenden Filialen der Migros Basel für jeweils 1 Franken eine Räbe, ein Holzstäbchen, ein RechaudKerzchen und ein Liederbüchlein abgeholt werden: Birsfelden, Breitenbach, Claramarkt, DrachenCenter, Schönthal, Liestal, Paradies, Riehen, Oberwil und MParc Dreispitz. In allen anderen Filialen sind die Räben auf Bestellung erhältlich.















5.60 «Aus der Region.» Kartoffeln festkochend Sack, 5 kg, (1 kg = 1.12)
Angebote gelten nur vom 15.10. bis 21.10.2024,






Migros Bio Karotten Schweiz, Beutel, 2 kg, (1 kg = 2.80)





Äpfel Gala, süsslich Schweiz, Box, 6 kg, (1 kg = 2.82)
Migros Basel

Aesch
Die drei Käsesorten, die im FCB-Fondue die besondere Mischung ausmachen, reifen in der Fromagerie des FranchesMontagnes im jurassischen Le Noirmont.
Regional verankert, eine traditionsreiche Geschichte und beliebt: Die Migros Basel, die MIBA Genossenschaft und den FC Basel 1893 verbindet vieles. Das FCB-Fondue steht seit Kurzem für diese Werte.
Text: Luzia Schmid
Es ist eine einzigartige Fonduemischung, die die MIBA Genossenschaft in Aesch entwickelt hat und dort seit Kurzem produziert – und sie ist nur in den Filialen der Migros Basel erhältlich. In ihr stecken die drei Käsesorten Le Noirmont, Taignon und Franches-Montagnes, alle drei hergestellt in der Fromagerie des Franches-Montagnes im jurassischen Le Noirmont. «Das FCBFondue ist sehr würzig und hat einen eigenen Charakter», sagt Claudio von Felten, Leiter Handel bei der MIBA. Und auch der Wein, der die Mischung abrundet, stammt aus der Region. Es ist ein Cuvée blanc Riesling-Sylvaner / Gutedel AOC Basel-Landschaft des Tschäpperli-Weinguts in Aesch. Das «Aus der Region. Für die Region.»-Fondue wird denn auch nicht nur die Fussballfans begeistern. Doch was hat die urschwei-
«Wie der FC Basel und die Migros sind wir eine regionale Institution mit einer langen Tradition.»
Claudio von Felten, Leiter Handel bei der MIBA
zerische Spezialität für kalte Winterabende mit Shaqiri, Xhaka und dem Joggeli zu tun –oder wie kam das Kind überhaupt zu seinem Namen? 1905 als Verband nordwestschweizerischer Milch- und Käsereigenossenschaften gegründet, vereint die MIBA heute rund 1200 Mitglieder aus den Kantonen Baselland, Basel-Stadt, Aargau, Bern, Jura und Solothurn.
«Unsere Motivation ist es, Wertschöpfung zu generieren und möglichst viel Milch unserer Bäuerinnen und Bauern zu verarbeiten», betont von Felten. «Wir leben die Regionalität – und mit der Migros und dem FC Basel haben wir zwei Partner gefunden, die für die gleichen Werte stehen.» Mit über 1200 Produkten bietet die Migros Basel das grösste regionale Sortiment der Nordwestschweiz. «Unser Qualitätslabel ‹Aus der

















Hier zum Rezept: Buttermilk-Chicken






3.60 Optigal Pouletbrust Medaillons
Schweiz, per 100 g, in Selbstbedienung



1.90 Optigal Poulethackfleisch
Schweiz, per 100 g, in Selbstbedienung
Angebote gelten nur vom 15.10. bis 21.10.2024, solange Vorrat.



3.30 Optigal Pouletschnitzel

Schweiz, 2 Stück, per 100 g, in Selbstbedienung






1.80 Optigal Poulet Schenkelsteaks
Schweiz, per 100 g, in Selbstbedienung ohne Knochen


5.70

M-Classic Lammrack
Australien/Neuseeland, per 100 g, in Selbstbedienung



Paillard, IP-SUISSE per 100 g, in Selbstbedienung 23%
3.–statt 3.90
Schweinsnierstück
Genossenschaft Migros Basel
Migros Basel

Käsermeister
Jean Philipp Tournier verarbeitet jährlich fast fünf Millionen Kilogramm Milch von Bauern aus Le Noirmont und Umgebung.
Irene Baucina bereitet die Fonduemischung in der MIBA in Aesch zum Abfüllen vor.

Region. Für die Region.› steht für eine nachhaltige Produktion, kurze Transportwege und innovative Prozesse», erklärt Naim Berisha, Fachbereichsleiter Molkerei bei der Migros Basel. Und auch die MIBA engagiert sich in der Region für eine nachhaltige Milchproduktion. «Wie der FC Basel und die Migros sind wir ausserdem eine regionale Institution mit einer langen Tradition», ergänzt Claudio von Felten. Für die RotBlauen ist es das Jahr 1893, die MIBA wurde 1905 gegründet, und die Genossenschaft Migros Basel feiert in sechs Jahren ihr 100-jähriges Bestehen.
Gemeinsam im Caquelon rühren Wenn die Tage wieder kürzer werden und die Abende zum gemütlichen Zusammensein einladen, ist ein FCB-Fondue genau das Richtige – ein Produkt ganz aus Zutaten aus der Region, das in der MIBA in Aesch mit viel Liebe zubereitet wird. «Die Regionalität und die Verbundenheit mit Basel haben uns zusammengeführt», sagt auch Fabian Hänggi, Partner Manager beim FCB. «Da gehört die Migros einfach dazu.»
Die Super League steckt derweil mitten in der entscheidenden Phase vor der Winterpause und lockt Woche für Woche zahl-
reiche Fans ins Joggeli. Die Temperaturen werden in diesen kommenden Monaten hier und dort für klamme Finger sorgen. Mit dem neuen FCB-Fondue lassen sich diese nach dem Spiel daheim in der warmen Stube rasch wieder aufwärmen. Und beim gemeinsamen Rühren im Caquelon kann man sich auch wunderbar über glanzvolle Tore freuen – oder über verpasste Chancen aufregen. Die würzige Käsespezialität dazu gibts in allen Filialen der Migros Basel.

«Aus der Region»-Fondue 600 g Fr. 17.95
Genossenschaft Migros Basel
Wahlwiderruf
Wahl einer Mitarbeitendenvertretung für den Rest der Amtsperiode 2024–2026
Liebe Mitglieder
Auf die Information in unserer Eigenpresse vom 2. September 2024 betreffend die Wahl eines Mitarbeitendenvertreters bzw. einer Mitarbeitendenvertreterin in die Verwaltung wurden keine Wahlvorschläge eingereicht.
Die Verwaltung und der Genossenschaftsrat haben den Wahlvorschlag, welcher durch die Mitarbeitenden der Genossenschaft unterbreitet wurde, am 20. bzw. 27. August 2024 verabschiedet.
Nach Art. 38 unserer Statuten sind demnach stille Wahlen durchzuführen, sodass wir den angesetzten Wahlgang als widerrufen erklären können.
Die 38-jährige Miranda Mehmetaj, Centerleiterin MParc Dreispitz, ist somit als Mitarbeitendenvertreterin der Verwaltung für den Rest der Amtsperiode 2024–2026 gewählt.
Wir gratulieren Frau Mehmetaj zur Wahl und wünschen ihr viel Erfolg in ihrer Funktion.
Genossenschaft Migros Basel
Die Verwaltung 14. Oktober 2024
migros-engagement.ch

Migros-Engagement fördert kulturelle und gesellschaftliche Initiativen. Wir engagieren uns. Für die Gesellschaft, die wir sein können.
Magnesium-Diasporal® activ direct versorgt Ihren Körper mit Magnesium und trägt zur Deckung eines erhöhten Bedarfs bei – ideal für Aktive und beim Sport.

Berocca® MED beugt dem Vitamin- und Mineralstoffmangel bei erhöhter nervlicher oder körperlicher Belastung vor.

Brausetabletten Cassis, 45 Stk. 40.95 statt 51.20
Magnesium-Diasporal® activ direct
60 Sticks 43.10 statt 53.90
Doetsch Grether AG

Die Cetaphil Pro Dryness Hautpflegelinie unterstützt bei trockener, Irritation Control zusätzlich bei irritierter und juckender Haut.
Brausetabletten Orange, 60 Stk. 47.60 statt 59.50 Filmtabletten, 100 Stk. 56.80 statt 71.00
Dies ist ein zugelassenes Arzneimittel. Lesen Sie die Packungsbeilage. Bayer (Schweiz) AG

Biotin-Biomed® forte 5 mg wird angewendet bei Haar- und Nagelwachstumsstörungen als Folge von Biotinmangel.
Cetaphil Pro Dryness & Irritation
Control z. B.
Repair sensitive Handcreme, 50 ml 8.80 statt 11.00
Galderma SA
DIESE AKTIONEN SIND GÜLTIG VOM 01. – 31. OKTOBER 2024

STANDORT-FINDER
Unser Standort-Finder zeigt Ihnen den Weg zu den nächstgelegenen
Rotpunkt Apotheken und bietet zusätzlich Informationen zu deren Serviceleistungen und Zugänglichkeit: www.rotpunkt-apotheken.ch/ apotheken

Biotin-Biomed® forte 5 mg
Tabletten, 90 Stk. 74.15 statt 92.70
Dies ist ein zugelassenes Arzneimittel. Lesen Sie die Packungsbeilage. Biomed AG


Penicillin-Pilz in Nahaufnahme. Daraus entstanden die ersten Antibiotika.
Sechs Gründe, die dafür sprechen, dass Pilze einige unserer grössten Probleme lösen werden. Oder zumindest dabei helfen könnten.
Text: Dinah Leuenberger
Steinpilze, Eierschwämmli und Portobello sind hübsch anzusehen und schmecken. Aber die Welt der Pilze reicht viel weiter als vom Waldboden auf den Teller. Denn der sichtbare Pilz, der Fruchtkörper, ist nur ein kleiner Teil des riesigen Pilzorganismus. Viel grösser sind die Myzelien: Das sind unterirdische, fadenförmige Strukturen, die Nährstoffe aus dem Boden absorbieren und durch die sich die Fruchtkörper ernähren.
Forschende gehen davon aus, dass es weltweit drei bis sechs Millionen Pilzarten gibt, etwa 150 000 sind bekannt, 350 davon sind essbar. Ein Pilz in Oregon gilt als der grösste lebende Organismus – sein unterirdisches Netzwerk ist grösser als 1300 Fussballfelder.
Trotz der bemerkenswerten Zahlen spielten Pilze in Wissenschaft und Industrie lange eine Nebenrolle. Ihre Erforschung war sogar eine Weile von der Kirche verboten, weil sie die spezielle Arbeit mit Pilzen den Hexen zuschrieb und deshalb Bücher mit Pilzwissen verbrannte. Heute boomt die Wissenschaft der Pilze, die Mykologie, aus diversen Gründen: Man hat entdeckt, dass Pilze organisches Material fressen können. Landwirtschaft und Medizin wollen nicht mehr nur auf Chemie setzen, sondern suchen nach weniger aggressiven Lösungen. «Pilze könnten helfen, einige Probleme des Klimawandels anzugehen», sagt Patrik Mürner, Mykologe und Gründer von mycosuisse.ch, dem Kompetenzzentrum für Mykologie. Er ordnet ein: «Obwohl wir schon einiges Wissen gesammelt haben, sind wir erst am Anfang. Aber ich glaube, dass Pilze mit etwas Zeit tatsächlich die Welt verändern werden.»
Auch Katia Gindro, Leiterin der Forschungsgruppe Mykologie bei Agroscope, dem Kompetenzzentrum des Bundes für landwirtschaftliche Forschung, spricht von idealen Verhältnissen für die Forschung: «Allein in einem Wassertropfen finden sich 10 bis 15 verschiedene Pilze. Alle lassen sich erforschen und haben womöglich spektakuläre Fähigkeiten.» Beide Experten, Katia Gindro und Patrik Mürner, sehen in den folgenden Bereichen Chancen, dass Pilze die Lösung für einige menschengemachte Probleme sein könnten.
Myzelien bilden unterirdische fadenartige Netzwerke, die mit blossem Auge nicht erkennbar sind.


«Obwohl wir schon einiges Wissen gesammelt haben, sind wir erst am Anfang. Aber ich glaube, dass Pilze mit etwas Zeit tatsächlich die Welt verändern werden.»
Patrik Mürner, Mykologe
Harte Kerle: Durch unterschiedliche Verarbeitung entsteht aus Pilzen hartes Material.
1. Pilze als Materialquelle
Pilze können sehr dichte Netzwerke bilden, indem sich ihre Myzelien miteinander verbinden. Daraus entstehen robuste Materialien, die biologisch abbaubar sind. Manche werden bereits in der Baubranche eingesetzt, zum Beispiel als Wärmeschutz. Auch eine Art Leder kann aus Pilzmyzel gewonnen werden. Damit können Kleidung und Schuhe hergestellt werden. Die Firma Adidas hat kürzlich einen Schuh auf Pilzbasis kreiert. Darüber hinaus können Pilze zur Herstellung von Verpackungsmaterialien verwendet werden, um Plastik einzusparen. Die Basler Firma Mycrobez, die vom Migros-Pionierfonds unterstützt wird, entwickelt aus Bioabfall und Pilznetzwerken Naturschaumstoffe.
Künftig anders düngen? Dank Pilzen vielleicht bald möglich.

2. Pilze in der Landwirtschaft Pilze haben das Potenzial, die Landwirtschaft zu revolutionieren. Sogenannte sekundäre Metaboliten können als Düngemittel oder als Fungizide genutzt werden –also Pilze gegen Pilze. Dadurch kann der Einsatz von Chemikalien in der Landwirtschaft reduziert und somit die Umweltbelastung verringert werden. Auch können bestimmte Pilze, die gezielt an den Wurzeln von Baumsetzlingen oder Getreidesamen platziert werden, deren Versorgung mit Wasser und wichtigen Nährstoffen fördern.
Fortsetzung auf Seite 55

Bei diesem Angebot sind bereits reduzierte Artikel ausgenommen.
Angebot gilt vom 15.10. bis 28.10.2024, solange Vorrat. Erhältlich in grösseren Migros-Filialen.



Bei allen Angeboten sind bereits reduzierte Artikel ausgenommen. Angebote gelten vom 15.10. bis 28.10.2024, solange Vorrat.









Fortsetzung von Seite 53

3. Pilze als Nahrung
Bereits seit den 1980er-Jahren werden aus Pilzmyzel mittels Fermentation Fleischalternativen wie Quorn hergestellt. Basierend auf diesem Wissen und der sich immer weiterentwickelnden Technologie kreieren aktuell Lebensmittel-Start-ups auf der ganzen Welt neuartige Nahrungsmittel auf Pilzbasis. Diese liefern wertvolle Nährstoffe und lassen sich relativ umweltschonend herstellen, da sie in der Regel wenig Wasser, Platz und Energie benötigen. Die Forschung geht davon aus, dass Pilze künftig eine deutlich grössere Rolle spielen werden, wenn es um die Ernährungssicherheit der Menschheit geht.
Quorn, der vielseitige Fleischersatz, entsteht aus einem Pilz.

Pilze können auch Plastik fressen – eine Kampfansage an Mülldeponien.
4. Pilze als Allesfresser
Pilze sind die ultimativen Recycler der Natur – zumindest sind heute vier Pilzarten bekannt, die genau das tun. Sie können nahezu jedes organische Material zersetzen, einschliesslich Baumaterialien wie Beton und Plastik. Sie tun dies, indem sie Enzyme in ihre Umgebung freigeben, die komplexe organische Verbindungen trennen, deren Bestandteile sie als Nährstoffe aufnehmen. Diese Fähigkeit könnte bald genutzt werden, um Abfall zu zersetzen und so zur Lösung des weltweiten Abfallproblems beizutragen.
«Allein in einem Wassertropfen finden sich 10 bis 15 verschiedene Pilze.»
Katia Gindro, Mykologin
Bei Erdölunfällen werden schon heute Pilze eingesetzt, um verschmutzte Böden zu reinigen.

5. Pilze als Medizin
Pilze produzieren bestimmte chemische Verbindungen, die bereits erwähnten sekundären Metaboliten, die ihnen helfen, mit anderen Organismen zu kommunizieren oder schädliche Mikroorganismen abzuwehren. Ein bekanntes Beispiel dafür ist Penicillin. Das Antibiotikum wird von bestimmten Arten von Schimmelpilzen produziert und tötet Bakterien. Neben Penicillin stammen auch viele weitere Arzneimittel von Pilzen ab oder enthalten Pilzelemente. Ihre Fähigkeit, diese Moleküle zu produzieren, macht Pilze zu einer wichtigen Ressource in der medizinischen Forschung und Behandlung. So wird zurzeit erforscht, ob Pilze aus dem Meer in der Krebstherapie eingesetzt werden können.
Weltweit wird fleissig an neu entdeckten Pilzen geforscht, um neue Medikamente zu entwickeln.

6. Pilze als Retter der Natur
Pilze sind in der Lage, verschmutzte Böden zu reinigen. Sie können Schwermetalle und andere organische Gifte wie Erdöl aufnehmen und neutralisieren. Man setzt sie zum Beispiel ein, wenn ein Öltanker ausgelaufen ist oder wenn bei stillgelegten Fabriken verschmutzte Böden zurückbleiben. Die Pilze reinigen durch ihre Eigenschaften die Böden. Und weil Pilze grossflächige unterirdische Netze bilden, können sie miteinander kommunizieren. Fehlt etwa einem Baum ein Nährstoff, schlägt das Pilznetzwerk Alarm und sorgt dafür, dass dem Baum der Nährstoff wieder zugeführt wird.
6.95 Carambar Family 800g







Bei allen Angeboten sind bereits reduzierte Artikel ausgenommen. Angebote gelten vom 15.10. bis 21.10.2024, solange Vorrat.


Dann erreichen wir Sie innerhalb kürzester Zeit überall in der Schweiz.
Jetzt Gönnerin oder Gönner werden



Schmeckt nach Abenteuer.
Snacks für die ganze Familie –mit kinderfreundlichen Rezepturen & wenigen Zutaten.



Bei allen Angeboten sind bereits reduzierte Artikel ausgenommen. Angebote gelten vom 15.10. bis 28.10.2024, solange Vorrat. alternativ gesüßt mild gewürzt




20x CUMULUS
Neu


2.70 Pizza Stangen
Knackige Stangen mit Olivenöl, italienischen Kräutern & aromatisch gereiftem Käse, 75 g

20x CUMULUS
Neu


3.80 Kakao Kekse
Knusprige Butterkekse mit Dinkel & Kakao, 125 g

«Wir haben plötzlich viel mehr
Saal»
Klassische Musik mit einem neuen Dreh: Das will das Konzertformat Classics 180° des Migros-Kulturprozents. Intendant Mischa Damev erklärt, was zu erwarten ist.
Text: Pierre Wuthrich
Mischa Damev, warum ein neues Konzertformat?
Die Welt entwickelt sich weiter, aber die klassische Musik ist seit über 100 Jahren in einem engen Korsett aus strengen Regeln gefangen. Deshalb wenden sich vor allem junge Menschen von ihr ab, weil sich Klassik für sie in einem verstaubten Museum mit hohen Mauern abspielt – obwohl sie Ravel oder Mozart nicht abgeneigt sind.
Was erwartet uns konkret?
Wir veranstalten weniger Konzerte und mehr Shows, experimentieren mit verschiedenen Disziplinen wie Tanz und Pantomime, manchmal mit spektakulären Lichteffekten.
Lenkt das nicht von der Musik ab?
Im Gegenteil. Durch solche Inszenierungen lässt sich die Botschaft eines Werks besser



Ein einziger Zigarettenstummel verschmutzt bis zu 1000 Liter Wasser. Millionen giftiger Stummel gelangen Jahr für Jahr in die Ozeane. Hier können Sie helfen, die Ozeane und ihre Bewohner vor Littering zu schützen: oceancare.org/plastik



vermitteln. Eine Partitur gibt nur einen Teil dessen wieder, was der Komponist oder die Komponistin beabsichtigt hat. Es liegt dann an den Interpreten, das Werk auf ihre Weise zum Leben zu erwecken. Zudem machen wir nichts Neues: Schon vor 300 Jahren waren die Konzerte von Farinelli oder Paganini inszenierte Spektakel mit Kerzenlicht und ständigen Kostümwechseln.
Sind die Musiker bereit, ihre Komfortzone zu verlassen?
Mehr denn je, ja. Das erfordert natürlich mehr Vorbereitung, denn das Orchester spielt jetzt oft auswendig. Aber: Je mehr Arbeit hinter den Kulissen geleistet wird, desto aussergewöhnlicher kann das Ergebnis sein. Ausserdem interpretieren die Musiker die Werke unter diesen Bedingungen anders, indem sie sich beispielsweise von den Tänzerinnen und Tänzern inspirieren lassen. Es entsteht ein Dialog.
Haben Sie keine Angst, das Stammpublikum zu verlieren?
Wir haben das Format vergangenes Jahr bei einem Konzert ausprobiert und festgestellt, dass wir nicht nur viel mehr junge Leute im Saal hatten, sondern dass auch die grosse Mehrheit der Stammgäste diese Neuerung schätzte. Das ist normal: Es ist immer schön, etwas Neues zu entdecken.

1. Das Aurora Orchestra setzt Strawinskys «Feuervogel» durch die Verbindung von Sprache, Choreografie und Instrumentalspiel humorvoll in Szene. Im ersten Teil erwartet das Publikum eine Überraschung.
2. Das Orchester Les Siècles (Bild oben) verwandelt Musik in Bilder. Während das Orchester Ravel spielt, wird der Illustrator Grégoire Pont live auf seinem Tablet Animationen entwerfen. Seine Werke werden dann auf einer grossen Leinwand erscheinen.
3. Das Geneva Camerata spielt Mozart und Lully wie kein anderes Orchester weltweit. Die Musikerinnen und Musiker sind Teil der Choreografie und tanzen mit zwei Profis.

Für Ohren und Augen: Das Orchester Les Siècles spielt zu Liveanimationen.
Tickets gewinnen
Die «MigrosKulturprozentClassics» laden Stars aus aller Welt ein, mit dem Ziel, klassische Musik zu moderaten Preisen einem breiten Publikum zugänglich machen. In Zürich, Luzern und Bern gibts Tickets für Studierende, Lernende und Jugendliche unter 25 Jahren schon ab fünf Franken.
Jetzt kannst du 10 × 2 Tickets für das Konzert deiner Wahl gewinnen.
Hier gehts lang:
Verändert Ihr Leben
Bereitet Ihnen die Benutzung Ihrer Haustreppe Probleme?
Tausende Menschen überlegten, ihre Häuser zu verlassen, weil sie sich unsicher fühlten oder Schmerzen hatten, wenn sie ihre Haustreppen benutzten. Glücklicherweise fanden sie Stannah zuerst! Stannah ist der führende Anbieter von Treppenliften, der Menschen dabei hilft, sich frei zwischen den Stockwerken zu bewegen, um ihre Unabhängigkeit und innere Ruhe wiederzuerlangen.



Senden Sie uns Ihre Gratisinformationen
Name: Vorname:
Strasse:
PLZ / Ort:
Telefon:
Zeit für Süsses oder Saures: Wie du schnell zum passenden Halloweenkostüm, einem geschminkten Gesicht und zu süssen Snacks für dein kleines Monster kommst.
Text: Edita Dizdar


Will dein Kind geschminkt auf Süssigkeitenjagd? Kein Problem. Verteile grüne Fasnachtsschminke im Gesicht, male mit Schwarz ein paar Narben auf Backen und Stirn und kleide dein Kind in dunkle Teile samt Jackett, gern auch in Übergrösse. Frankensteins Monster ist auferstanden! Auch der Zombie-Look lässt sich leicht kreieren: Das Gesicht weiss bemalen, ein paar dunkle Augenringe darüber und etwas rote Farbe für Blut, das aus Nase oder Mund läuft – fertig. Dazu ein zerrissenes Oberteil und eine Hose mit Löchern an den Knien kombinieren.


Die einfachste Verkleidung ist der Geist: Schnapp dir ein weisses Laken, schneide zwei Gucklöcher rein und ziehe es deinem Kind über. Darunter passt warme Kleidung. Fast ebenso unkompliziert: Wickle den Nachwuchs ordentlich mit WC-Papier ein. Voilà, eine Mumie. Das funktioniert allerdings nur, wenns nicht regnet. Die robustere Variante: Hol alle Verbände raus, die du in deinem Erste-Hilfe-Kasten finden kannst. Achtung: Den Gang aufs Klo nicht vergessen, bevor aus dem Kind eine Mumie wird. Tipp drei: Ein dunkles Outfit und ein schwarzer Nylonstrumpf übers Gesicht gezogen, machen im Nu kleine Einbrecherinnen und Einbrecher. Mit einem Stoffbeutel ist das Kostüm komplett.


Halloween-Deko muss nicht aufwendig sein. Stelle am 31. Oktober für die Stimmung ein paar Speisekürbisse auf, etwa auf dem Esstisch oder vor der Eingangstür. Ist der Spuk vorbei, kannst du sie in den Tagen danach zu feinen Familienmenüs verarbeiten. Hinter und unter Möbeln versteckte Lichterketten sorgen für ein gespenstisches Ambiente. Oder du machst einfache, gruselige Windlichter: Dafür nimmst du weisse Sandwichbeutel, lässt dein Kind mit schwarzem Filzstift böse Augen und einen verzerrten Mund draufmalen und stellst ein leeres Konfiglas samt Teelicht hinein. Am nächsten Tag verwendest du die Tüten dann fürs Znüni.
Gibts in der Migros


Damit die Nachbarskinder nicht leer ausgehen, wenn sie vor deine Tür kommen, kaufst du eine fertige Süssigkeitenmischung. Eine gute Show vertuscht das unaufwendige Angebot: Schalte das Licht im Eingangsbereich deiner Wohnung aus und streck die süsse Belohnung hinter der Tür hervor, ohne dich selbst zu zeigen. Ein paar furchterregende Geräusche machen zusätzlich Eindruck.

Wildschweine
Im Herbst gibt es in den Wäldern besonders viel Futter für Wildschweine.
Darum sind die Tiere häufiger unterwegs.
Doch was tun bei einer Begegnung?
Die wichtigsten Fragen und Antworten.
Text: Barbara Scherer
Wer ist das Wildschwein?
Das Wildschwein ist der direkte Vorfahre des Hausschweins. Es hat ein dickes, dunkles Fell und kann bis zu 1 Meter hoch werden. Weibchen, die Bachen, sind kleiner und leichter als männliche Tiere – Eber oder Keiler genannt. Ein grosser alter Keiler bringt bis zu 200 Kilogramm auf die Waage.
Wann ist das Wildschwein unterwegs? Eigentlich können die Tiere den ganzen Tag aktiv sein. Weil der Mensch die Wildschweine stört, sind sie meist nachtaktiv. «Am ehesten sieht man sie ohne weitere Hilfsmittel morgens und abends, wenn sie vom Ruheplatz zum Futterplatz oder umgekehrt wechseln», sagt Jagdexperte Reto Fischer.
Was frisst das Wildschwein?
Wie viele gibt es in der Schweiz?
Die Tiere sind hierzulande weitverbreitet, und es ist schwierig, ihre Anzahl zu bestimmen. «In den vergangenen Jahren wurden zwischen 8000 und 13 000 Wildschweine in der Schweiz erlegt, und es gibt sicher mehrere Zehntausend», sagt Reto Fischer, Fachspezialist Jagd beim Kanton Aargau.
Wie alle Schweine ist auch das Wildschwein ein Allesfresser. Ausser Gräser und Früchte essen die Tiere auch Eier und kleine Säugetiere sowie Aas.

Wie lebt es?
Wildschweine leben in sogenannten Rotten zusammen, die aus Muttertieren und ihren Jungtieren, den Frischlingen, und anderen Weibchen (Bachen) bestehen. Eine Leitbache führt die Gruppe an. Junge Männchen (Keiler) leben auch in Gruppen zusammen, während ältere Männchen allein unterwegs sind. Sie schliessen sich nur während der Paarungszeit ab Spätherbst einer Rotte an.




















































Wildschweine

Immer öfter dringen Wildschweine in Wohngebiete vor – warum?
«Wildschweine sind flexible Tiere und probieren vieles aus», erklärt Wildschweinforscher Stefan Suter. «Gibt es eine Nahrungsquelle in einem Wohngebiet, gehen sie dorthin.» Anders als zum Beispiel in Deutschland gibt es in der Schweiz keine Wildschweine, die permanent in der Stadt leben. Dafür gibt es in den Schweizer Städten zu wenig grosse verwilderte Grünflächen.
Wie schütze ich meinen Garten vor den Tieren?
Mit einem stabilen Zaun oder einem Elektrozaun, der regelmässig auf seine Funktionstüchtigkeit kontrolliert werden muss. Ist er ausgeschaltet, merken das die Wildschweine sofort.
Was tun bei einer Begegnung?
«Solange das Wildschwein nicht auf einen zukommt, langsam weggehen und den allenfalls frei laufenden Hund anleinen», so Reto Fischer. Meistens entfernen sich die Tiere, wenn sie Menschen wahrnehmen. Gefährlich wird es, wenn man an ein Muttertier mit Jungen gerät oder ein verletztes Tier findet. «Flüchtet ein verletztes Wildschwein nicht, sollte man sich keinesfalls nähern, sondern die örtliche Jagdaufsicht oder Wildhut kontaktieren», sagt Fischer. Bei einem Angriff laute Geräusche machen und Deckung suchen, am besten in die Höhe klettern. Bei einer Konfrontation die Beine eng zusammenschliessen. «Mit den Eckzähnen können Wildschweine sehr tiefe Wunden reissen.»
Wer sind die Feinde des Wildschweins?
Der Wolf, der Luchs und grosse Greifvögel, die Jungtiere erbeuten, sind die natürlichen Feinde der Wildschweine. Die grösste Gefahr für sie ist aber mit Abstand der Mensch. Hierzulande wird der Bestand durch gezielte Jagd reguliert.
Warum werden die Tiere immer häufiger ein Problem?
Die Wildschweinbestände nehmen seit den 90erJahren in der Schweiz stetig zu. «Gleichzeitig gibt es mehr Menschen, der Lebensraum der Tiere schrumpft», erklärt Wildschweinforscher Stefan Suter von der Zürcher Hochschule für Angewandte Wissenschaften. Deshalb verursachen die Tiere zunehmend Schäden in der Landwirtschaft, weil sie die Böden nach Nahrung durchwühlen und Nutzpflanzen zerstören.













Ob im Familienleben, bei der Arbeit oder während Freizeitaktivitäten; wir sind dauernd gefordert unser Bestes zu geben. Daher ist es wichtig, körperlich und geistig vital zu sein und stets in Schwung zu bleiben. Insbesondere in Zeiten erhöhter Belastung, sowie im Herbst und Winter wird unser Immunsystem stark beansprucht, damit wir den Herausforderungen des Alltags gesund und fit begegnen können.
Eine tägliche Portion an Vitaminen und Mineralstoffen ist wichtig und unterstützt die Vitalität sowie das Immunsystem



Um gesund und in Schwung zu bleiben ist der menschliche Organismus auf eine ausreichende Versorgung mit Vitaminen und Mineralstoffen angewiesen. Idealerweise werden diese durch eine ausgewogene Ernährung mit viel Obst und Gemüse zugeführt. Individuelle Essgewohnheiten, das saisonbedingte Wegfallen von Lieblingsfrüchten oder der Mangel an Disziplin sich gesund zu ernähren, erschweren es jedoch so manchem, den täglichen Bedarf an Vitaminen und Mi-
Gemü Essge
Lieblingsfrüch Diszi täg
Der hochdosierte Vitamin- und Mineralstoffschub für Alt und Jung aus der Migros:
Axamine multiVit Sticks enthalten 13 Vitamine und 10 Mineralstoffe sowie Fruchtpulver aus Bana ne, Ananas, Passionsfrucht, Aprikose und Pfirsich. Die praktischen Direktsticks ermöglichen eine an genehme Einnahme ohne Flüssigkeit.
Axamine multiVit ist auch erhältlich als Toffees für die ganze Familie. Die leckeren Toffees mit Sanddorn-Aroma enthalten neben 13 hochdosier ten Vitaminen 3 Mineralstoffe fürs Immunsystem das Wachstum und die Entwicklung
Axamine multiVit – in Schwung von Alt bis Jung!

neralstoffen zu sich zu nehmen. Eine vorübergehende Supplementierung mit Vitaminen und Mineralstoffen kann daher sinnvoll sein. Hierbei können Nahrungsergänzungsmittel den zusätzlichen Bedarf an Vitalstoffen bereitstellen. Wichtig ist jedoch darauf zu achten, sich für ein qualitativ hochwertiges Produkt zu entscheiden, welches optimal dosiert ist und sich für die tägliche Einnahme als praktisch, wie auch angenehm erweist. Bei der Wahl von Vitaminpräparaten lohnt es sich daher zu vergleichen, und nicht einfach nach dem billigsten Produkt im Regal zu greifen.























40%
Plenty
Vorteilspacks, z.B. Plenty Original 16x45 Tücher, 15.50 statt 25.85
1Die Tücher sind heimkompostierbar nach NF T 51-800 und industriell kompostierbar nach EN 13432/ EN 14995. Die Entsorgung in der Biotonne kann eingeschränkt und von Region zu Region unterschiedlich sein. Bitte erkundigen Sie sich bei den lokalen Entsorgungsbetrieben. Für die Kompostierung stellen Sie bitte sicher, dass die Tücher nicht in Verbindung mit nicht kompostierbaren oder gefährlichen Stoffen verwendet wurden.
Bei diesem Angebot sind bereits reduzierte Artikel ausgenommen. Angebot gilt vom 15.10. bis 28.10.2024, solange Vorrat
Eine nostalgische Schienenkreuzfahrt rund um die schönen Salzburger Adventsmärkte



Eine der beliebtesten Adventsreisen aus unserem Angebot. Rund um die schönen Salzburger Adventsmärkte erleben wir auf dieser Reise vorweihnachtliche Tage wie aus dem Bilderbuch! Mit nostalgischen Dampfzügen unternehmen wir wie zu Grossvaters Zeiten verträumte Fahrten durch die tief verschneiten Winterlandschaften und lassen es uns in guter Gesellschaft so richtig gut gehen.




4 Reisetage inkl. Halbpension ab nur

338




Ihr tolles Reiseprogramm:
1. Tag, Donnerstag 21. November 2024 –Salzburg & Anreise
Fahrt im komfortablen Extrabus nach Salzburg. Die Stadt erstrahlt im festlichen Weihnachtskleid und erwartet uns mit seinen bekannten Christkindlmärkten in der schönen Altstadt. Schlendern Sie beim Duft von Lebkuchen und Glühwein durch die verschiedenen Stände und lassen Sie sich verführen. Später Weiterfahrt zu unserem Hotel, wo wir mit dem Nachtessen erwartet werden.
2. Tag, Freitag 22. November 2024 –Adventszug der Schafbergbahn & Wolfganger Advent
Der Winter bringt die schönsten Seiten des Salzkammergutes zum Vorschein. Überall schmiegen sich bezaubernde Orte an die Ufer der zahlreichen Seen und die erhabene Bergwelt verleiht der Region ihren einmaligen alpinen Charakter. Die fantastische Bergwelt
erkunden wir nach dem Frühstück bei einer Fahrt mit dem Adventszug der legendären Schafberg-Bahn. Die steilste Dampf-Zahnradbahn Österreichs bringt uns durch den winterlichen Bergwald bis zur Station Schafbergalpe auf 1400m Höhe, wo wir in der einen wärmenden Punsch und die unglaubliche Aussicht über das Salzkammergut geniessen werden. Wieder unten im Tal besuchen wir den beliebten Wolfganger Advent. Bummeln Sie über den Markt und lassen Sie sich von der vorweihnachtlichen Freude anstecken. Nachtessen im Hotel.
3. Tag, Samstag 23. November 2024 –Steyrtalbahn & Ampflwang Museumsbahn
Heute Morgen fahren wir durch schöne Landschaften bis zum romantischen Städtlein Steyr, wo wir am Bahnhof von der stolzen Dampflok und historischen Waggons der legendären Steyrtalbahn erwartet werden.
Lehnen Sie sich zurück und freuen Sie sich auf eine historische Fahrt. Vorbei an der weltbe -

kannten Wallfahrtskirche Christkindl fährt unser Zug durch wunderbare Winterlandschaften bis nach Grünburg. Im Bahnhof Grünburg besichtigen wir die Fahrzeughalle und eine kleine Ausstellung über die Steyrtalbahn ehe uns in Timelkam die Ampflwang Museumsbahn zum nächsten winterlichen Nostalgieerlebnis erwartet. Am Abend erwartet uns im Hotel ein schönes Abschlussessen mit lokalen Köstlichkeiten.
4. Tag, Sonntag 24. November 2024Heimreise
Nach dem Frühstück treten wir mit vielen nostalgischen Adventseindrücken die Heimreise. an.

Noch mehr sparenbis 100% REKA-Checks!
Leistungen - Alles schon dabei!
✓ Fahrt im komfortablen Extrabus ins Salzburger Land/Salzkammergut
✓ 3 Übernachtungen im guten Mittelklassehotel
✓ 3 x ausgiebiges Frühstücksbuffet
✓ 3 x feines Nachtessen im Hotel
✓ Fahrt mit dem Dampfzug der legendären Steyrtalbahn (Steyr-Grünburg)
✓ Fahrt mit dem Adventsdampfzug der Schafberg- Bahn (St. Wolfgang-SchafbergAlpe- St. Wolfgang) inkl. wärmender Punsch
✓ Fahrt mit der Ampflwang Museumsbahn (Timelkam-Ampflwang)
✓ Besuch der Wolfganger Adventswelt
✓ Besuch der Christkindlmärkte in Salzburg
✓ Eigene Schweizer Reiseleitung während der ganzen Reise
Unser Sonderpreis für Sie:
Preise pro Person im Doppelzimmer im guten Mittelklassehotel Fr. 679.-
Nicht inbegriffen/zusätzlich wählbar: Einzelzimmerzuschlag nur Fr. 120.Buchungsgebühr: Fr. 24.- pro Person (entfällt bei Online-Buchung)
Sie wählen Ihren Bus-Einsteigeort: Aarau, Basel, Bern, Luzern, Pfäffikon SZ, St. Gallen, Sargans, Thun, Winterthur oder Zürich
2×

Löse das Kreuzworträtsel und gewinne eine von 2 Migros-Geschenkkarten im Wert von je 100 Franken.
Teilnahme unter: www.migmag.ch/raetsel
Teilnahmebedingungen Gewinnspiele: Teilnahmeberechtigt sind alle Personen mit Wohnsitz in der Schweiz und dem Fürstentum Liechtenstein, die das 18. Altersjahr vollendet haben. Von der Teilnahme ausgeschlossen sind die Mitarbeitenden des Gewinnspielveranstalters sowie Gewinnspielvereine, automatisierte Dienste und weitere professionalisierte/gewerbliche Teilnehmende. Gewinner/-innen werden schriftlich benachrichtigt und mit Namen und Wohnort veröffentlicht. Seit September 2023 ist die kostenlose Teilnahme an Verlosungen ausschliesslich online möglich.
Anzeige

Wir Blinden sehen anders, z. B. mit der Nase.
Selbstbestimmt durch den Alltag. Dank Ihrer Spende: szblind.ch






































2 × 100 Franken zu gewinnen
Ermittle für jede Quizfrage den richtigen Lösungsbuchstaben. Für das Lösungswort der Reihe nach in die Lösungsfelder eintragen. www.migmag.ch/quiz
Mit welchen Tieren überquerte Hannibal 218 v. Chr. die Alpen?
Wie viele Schweizer Berggipfel sind über 4000 Meter hoch?
Welche ist weltweit die meistverkaufte Single aller Zeiten?
Wie viele Meter sind 0,03 Kilometer?
Welcher Pass ist der höchste in der Schweiz?
F Bernina G Furka H Umbrail
Wem wird das berühmte Gemälde «Salvator mundi» zugeschrieben?
A Claude Monet E Leonardo da Vinci M Picasso
In China ist 2025 das Jahr ...
F der Ziege G des Hundes L der Schlange
× 100 Franken zu gewinnen
Fülle die leeren Felder mit den Zahlen 1 bis 9. Dabei darf jede Zahl in jeder Zeile, jeder Spalte und in jedem der neun 3×3-Blöcke nur ein Mal vorkommen. Die Lösungszahl ergibt sich aus den orangen Feldern von links nach rechts. www.migmag.ch/sudoku
Die Zahl bei jeder Spalte oder Zeile bestimmt, wie viele Felder durch Schiffe besetzt sind. Diese dürfen sich nicht berühren und müssen vollständig von Wasser umgeben sein, sofern sie nicht an Land liegen.
2 × 100 Franken zu gewinnen
Trage die zehn Wörter in das Rätselgitter ein. Das Lösungswort ergibt sich aus den Buchstaben in den Feldern 1 bis 5. www.migmag.ch/paroli

Rätsel online lösen & kostenlos teilnehmen: www.migmag.ch Teilnahmeschluss ist der Sonntag, 20.10.2024, um 24 Uhr. Die Teilnahmebedingungen findest du auf der ersten Rätselseite. Lösungen & Gewinner früherer Ausgaben: www.migmag.ch/raetsel

Bei allen Angeboten sind bereits reduzierte Artikel ausgenommen. Angebote gelten vom 15.10 bis 21.10.2024, solange Vorrat.

Bei diesem Angebot sind bereits reduzierte Artikel ausgenommen. Angebot gilt vom 15.10. bis 21.10.2024, solange Vorrat.








Die Subline kann ein Viertel, ein Drittel oder halb so gross sein, wie die Headline sein








Bei allen Angeboten sind bereits reduzierte Artikel ausgenommen. Angebote gelten vom 00.00. bis





































Ein Rezept, fünf Zutaten

M-Classic Rehschnitzel per 100 g Fr. 5.65

Champignons
250 g Fr. 2.40

Petersilie gekraust
30 g Fr. 1.50
Rote Zwiebeln
500 g Fr. 1.10




Alnatura
Condimento Bianco
500 ml Fr. 5.20
Und so gehts
300 g gemischte Pilze putzen, klein schneiden. 2 Zwiebeln in Spalten schneiden. ½ Bund Petersilie hacken. 2 EL Olivenöl in Bratpfanne erhitzen, Pilze scharf anbraten. Zwiebeln dazugeben, Hitze reduzieren. Mit 3 EL Essig ablöschen, 2–3 Minuten dünsten. Salzen und pfeffern. Pilze aus der Pfanne heben, beiseitestellen. In derselben Bratpfanne 2 EL Öl erhitzen, 4 Rehschnitzel scharf anbraten, salzen und pfeffern. Pilze beigeben, kurz braten. Mit Petersilie bestreuen. Dazu passen Kartoffelstock oder Salzkartoffeln. Mehr Wildrezepte auf migusto.ch

15. 10. – 21. 10. 2024



ab 3 Stück 33%


14.–
statt 23.45

Optigal Pouletgeschnetzeltes
Schweiz, 2 x 350 g, (100 g = 2.00)

4.–

3.30
statt 6.60

6 x 1.5 Liter, (100 ml = 0.04)
statt 5.80 Schweinsfilet, IP-SUISSE in Sonderpackung, per 100 g 30%


5.10 statt 9.–Longobardi Tomaten gehackt 6 x 400 g, (100 g = 0.21), gültig vom 17.10. bis 20.10.2024 6er-Pack 43%
Solange Vorrat. Bei allen Angeboten sind M-Budget und bereits reduzierte Artikel ausgenommen.


Gesamtes Farmer's Best Sortiment tiefgekühlt, z.B. Hackspinat, IP-SUISSE, 800 g, 2.70 statt 3.90, (100 g = 0.34) 30%



2.60
statt 3.90 Kalbshaxen, IP-SUISSE in Sonderpackung, per 100 g, gültig vom 17.10. bis 20.10.2024 33%
Alle Pampers Windeln (ohne Mehrfachpackungen), z.B. Premium Protection, Gr. 1, 24 Stück, 6.55 statt 9.75, (1 Stk = 0.27)
1.95
statt 2.95


Migros Bio Bananen, Fairtrade Kolumbien/Peru/Ecuador, per kg 33%
Gültig von Do – So Wochenend Knaller



Trauben weiss, kernlos Italien, Schale, 500 g, (100 g = 0.35), gültig vom 17.10. bis 20.10.2024 30%
1.75
statt 2.50